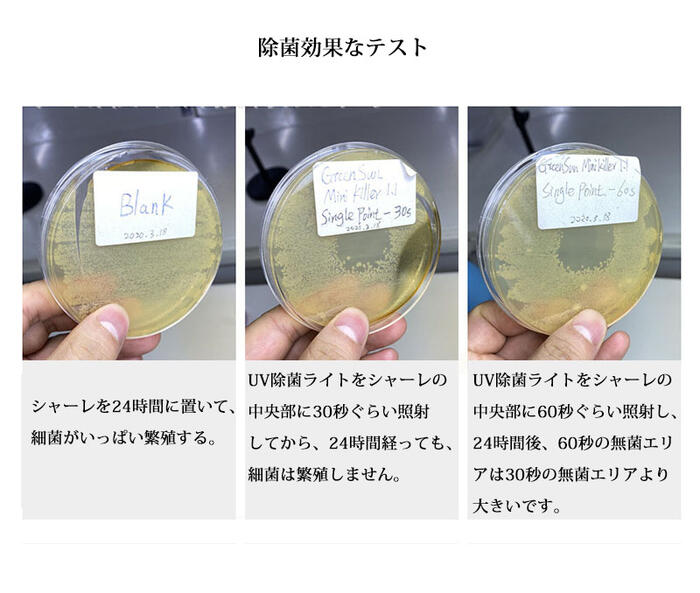

TEMUに負けない価額! ※バーバリブ
-
Fashion
- 注目商品
- 人気商品
- おすすめの商品
- メーカーショールーム
- 共同購入
- 今日の特価
- タイムセール
- 下着 レッグウェア
-
メンズバッグ シューズ 小物
- その他バッグ・財布
- マネークリップ
- バッグチャーム
- パスポートケース
- パーティーバッグ
- ネックストラップ
- ネクタイピン
- ドラムバッグ
- テンガロンハット
- つけ襟
- チロリアンハット
- チェーンベルト
- ダッフルバッグ
- タイベルト
- ソフトハット 中折れ帽
- その他ファッション小物
- その他サングラス
- スポーツメガネ
- スヌード ネックウォーマー
- ストローハット
- サブリュック
- サスペンダー
- ウエスタン カービングベルト
- 腕時計
- リュック デイバッグ
- メッセンジャー ボディ
- Fashionボストンバッグ
- Fashionヒップ ウエストバッグ
- ビジネス ブリーフケース
- Fashionトートバッグ
- Fashionsその他
- Fashionショルダーバッグ
- Fashionローファー
- ブーツ
- ビジネス
- Fashionその他
- スリッパ
- サンダル
- Fashionカジュアル
- Fashion長財布
- Fashion名刺入れ カードケース
- Fashion二つ折り財布
- Fashionその他財布
- Fashionコインケース
- Fashionキーケース
- Fashion眼鏡
- Fashion指輪 リング
- 手袋
- Fashion帽子
- メンズカジュアルベルト
- Fashionマフラー
- ペンダント チョーカー
- ブレスレット バングル
- ピアス
- Fashionネックレス
- チェーン
- その他小物
- Fashionサングラス
- カフス タイピン
-
Shoes
- 靴ケア用品
- その他シューズアクセサリー
- インソール効果 身長アップ
- 機能性シューズ
- その他スポーツシューズ
- スポーツ
- ウォーキング
- アクアシューズ
- アウトドア
- 厚底
- ワーク エンジニア
- ロング
- レースアップ
- レインブーツ
- ムートン
- ブーティー
- ニーハイ
- その他ブーツ
- ショート ノーマル
- ウエスタン フリンジ
- ローファー
- モカシン
- フラット
- その他シューズ
- 厚底スニーカー
- ローカットスニーカー
- レザースニーカー
- ハイカットスニーカー
- その他スニーカー
- スリッポン
- インヒールスニーカー
- ラウンドトゥ
- ポインテッドトゥ
- ピンヒール
- ハンドメードシューズ オーダーメードシューズ
- バレエシューズ
- その他パンプス
- スクエアトゥ
- オープントゥ
- ウェッジソール
- 厚底シューズ
- ミュール
- ビーチサンダル
- トング
- その他サンダル
- スリッパ 上履き
- ストラップ
- コンフォート サボ
- クロックス
- グラディエーター フォークロア
- Wedge sole
-
腕時計 ジュエリー
- 腕時計用パーツ
- キャラクター時計
- 腕時計レディース
- 腕時計メンズ
- 腕時計ペアウォッチ
- 懐中時計
- その他アクセサリー
- キーチェーン
- カメオ
- ウォレットチェーン
- 腕時計用ベルト
- 腕時計アクセサリー
- ケア 修理用品
- 男女兼用 腕時計
- メンズ腕時計
- フォーマル
- その他腕時計
- スポーツ アウトドア
- キャラクター
- カジュアル
- その他ブランド腕時計
- Vivienne Westwood
- TIMEX
- TECHNOS
- SWATCH
- SKAGEN
- SEIKO
- Salvatore Marra
- ORIENT
- NIXON
- Michael Kors
- MARC JACOBS
- Kate Spade
- GUESS
- GUCCI
- G-SHOCK
- FOSSIL
- Folli Follie
- DIESEL
- ダニエルウェリントン
- D&G
- COACH
- CITIZEN
- CASIO
- BOY LONDON
- Baby-G
- ARMANI
- Alessandra Olla
- adidas
- 指輪 リング
- ブレスレット アンクレット
- ピアス イヤリング
- ネックレス
- ジュエリーボックス ケア用品
- コサージュ ブローチその他
-
バッグ 雑貨
- ウェディング小物
- リストバンド 小物
- キーホルダー 小物
- アームカバー 小物
- バンダナ
- ハンカチ
- スカーフ
- 傘 日傘 折りたたみ傘
- その他傘
- 男女兼用
- レディースベルト
- その他ベルト
- 老眼鏡
- 眼鏡ケース
- 眼鏡
- フレーム
- その他眼鏡
- サングラス
- 耳あて イヤーマフラー
- ベレー帽
- ハンチング キャスケット
- ハット
- ニット帽
- その他帽子
- キャップ
- マフラー
- その他ストール マフラー
- スヌード
- ストール
- バッグインバッグ
- フルウィッグ
- ハーフウィッグ
- エクステンション つけ毛
- ヘアピン
- ヘアゴム シュシュ
- ヘアクリップ
- その他ヘアアクセサリー
- カチューシャ ヘアバンド
- 革手袋
- ニット手袋
- アームウォーマー
- 長財布
- 名刺入れ カードケース
- 二つ折り財布
- ポシェット
- ポーチ
- パスケース
- その他財布
- コインケース
- キーケース
- 旅行バッグ
- リュック デイパック
- マザーズバッグ
- ボディバッグ
- ボストンバッグ
- ヒップ ウエストバッグ
- ハンドバッグ
- バニティバッグ
- トートバッグ
- その他バッグ
- ショルダーバッグ
- クラッチバッグ
- キャリーバッグ
- かごバッグ
- エコバッグ
-
メンズファッション
- ジャケット アウター
- スウェット ジャージ
- パンツ・ボトムス
- 作業用ワークパンツ
- 作業用ポロシャツ
- 作業用ベスト
- 作業用ジャケット
- 作業用カーゴパンツ
- 着物セット
- 浴衣セット
- 一般作業向け作業靴
- 学生服上着
- 学生服上下セット
- 学生服パンツ
- 学生服コート
- 下駄
- 食品現場向け作業靴
- 和装コート
- 和服 作務衣
- 和服 足袋
- 和服 草履
- 安全靴
- ワークブーツ
- ワークシャツ
- レタードセーター
- レザーパンツ
- ユーチップ
- モンクストラップ
- ムートンコート
- ミリタリーブーツ
- ミリタリーシャツ
- ミドルカット
- マント
- まとめ売り 福袋
- マウンテンブーツ
- ボタンダウンシャツ
- ポケットチーフ
- ボウリングシャツ
- フリースジャケット
- フラップサンダル
- フライトジャケット
- ブーティブーツ
- ビットシューズ
- ビジネスサンダル
- バンプ
- バルカラーコート
- ノルディックセーター
- ネルシャツ
- ニットベスト
- トラックジャケット
- ドライビングシューズ
- デニムシャツ
- デッキシューズ
- デザートブーツ
- チルデンセーター
- チャッカブーツ
- ダンガリーシャツ
- ダブルモンク
- ダッフルコート
- タッセル
- ダウンベスト
- ダウンコート
- タートルネック・ハイネックセーター
- その他作業用上着
- その他作業靴
- その他作業服
- その他学生服
- その他靴・シューズ
- その他ニット セーター
- その他ジャケット・アウター
- その他サンダル
- その他カジュアルセットアップ
- スライダーサンダル
- スプリングコート
- スノーシューズ
- ストレートチップ
- ストラップサンダル
- ステンカラーコート
- スタジアムジャケット
- スクールシャツ
- スクール 革靴
- スカジャン
- スイングトップ
- ジョガーパンツ
- シャンブレーシャツ
- シャツジャケット
- サファリジャケット
- サイドゴアブーツ
- サイドエラスティックシューズ
- コンフォートサンダル
- コーチジャケット
- クルーネックセーター
- グラディエーターサンダル
- カプリシャツ
- カバーオール・ワークジャケット
- カジュアルジャケット
- カウチンセーター
- オーダースーツ
- オイルドコート
- ウエスタンブーツ
- ウエスタンシャツ
- ウールパンツ
- ウインドブレーカー
- ウィングチップ
- アロハシャツ
- アームガーター
- アーガイルセーター
- Vネックセーター
- 作業用インナー・コンプレッションウェア
- ローカット
- ベスト・ジレ
- リストバンド
- キーホルダー
- アームカバー
- 甚平
- 浴衣
- 和装小物 メンズファッション
- 水着
- 小さいサイズ
- 大きいサイズ
- 作業着
- その他 メンズファッション
- セットアップ メンズファッション
- 靴下
- 機能性インナー
- メンズレギンス タイツ
- ボクサーパンツ
- ブリーフ
- パジャマ ルームウェア
- トランクス
- その他 インナー
- アンダーシャツ
- ワイシャツ
- ベルト
- フォーマルスーツ
- ビジネスコート
- パンツ スラックス
- ネクタイ
- その他 メンズ ビジネス
- スーツセット
- ジャケット ブレザー
- オーダーメイド
- 革 ライダース
- ロングコート
- モッズ ミリタリー メンズ
- ポンチョ メンズ
- ベスト メンズ
- パーカー トレーナー
- トレンチ
- デニム
- テーラード
- ツイード
- ダウンジャケット
- その他 メンズ
- ジャンパー ブルゾン メンズ
- カーディガン メンズ
- Aライン ピーコート メンズ
- ロングパンツ メンズ
- ハーフパンツ
- トレーニングボトムス
- デニム ジーンズ メンズ
- その他 パンツ
- クロップドパンツ
- 長袖シャツ
- 半袖シャツ
- 七分袖シャツ
- ユニークデザイン
- ポロシャツ メンズ
- フード付き
- ニット セーター
- タンクトップ
- その他トップス
- カットソー
- カジュアルシャツ
- Tシャツ メンズ
-
Ladyレディース服
- キャミワンピ
- Aラインコート
- ピーコート
- レインジャケット・コート
- ライダースジャケット
- 足袋
- 制服・作業服
- 着物 色無地
- 着物 付け下げ
- 着物 訪問着
- 浴衣 下駄
- 浴衣 付け帯
- 伊達締め
- 一般作業向け靴
- 水着用シリコンブラ
- 甚平・作務衣
- 肌着・肌襦袢
- 和装小物 伊達衿
- 和装小物 髪飾り
- 和装小物 帯揚げ
- 和装小物 帯締め
- 和装小物 草履
- 和装小物 かんざし
- 和装帯 付け帯
- 和装帯 袋帯
- 和装帯 長襦袢
- 和装帯 半幅帯
- 和装ブラ
- 和装 羽織
- 和装 ショール
- 安全靴
- ワークブーツ
- レースアップパンプス
- レースアップサンダル
- レインパンプス
- リクルートパンプス
- リクルートスーツ
- ラップスカート
- モノキニ
- ムートンジャケット・コート
- ミリタリージャケット
- ミドルブーツ
- ミドルカットスニーカー
- まとめ売り・福袋
- マウンテンブーツ
- マーメイドスカート
- ボレロ
- ボアジャケット
- ペンシルスカート
- ペプラムスカート
- フリンジブーツ
- フリースジャケット・コート
- プラットフォームパンプス
- プラットフォームサンダル
- フラットサンダル
- ブラックフォーマル
- ブーツサンダル
- ブーツカットパンツ
- フィッシュテールスカート
- ファーベスト
- ファーブーツ
- ファーパンプス
- ファーサンダル
- ファーコート
- ビスチェビキニ
- ビスチェ
- ひざ下丈ワンピ
- ビーチタオル
- ビーチウェア
- バルーンスカート
- ハイウエストパンツ
- ハイウエストスカート
- パーティドレス
- パーティー用コート
- パーティーパンプス
- パーティーサンダル
- ノースリーブ
- ナイトドレス
- デッキシューズ
- ティアードスカート
- チャイナドレス
- チノパンツ
- タッセルシューズ
- ダウンベスト
- その他作業靴
- その他着物
- その他靴・シューズ
- その他和装小物
- その他レインシューズ
- その他ドレス
- その他オールインワン・サロペット
- スラックス
- スポーツサンダル
- ステンカラージャケット
- スタンドカラージャケット・コート
- スタジャン
- スカジャン
- ジョッキーブーツ
- ショートブーツ
- ジュートサンダル
- サブリナパンツ
- サイドゴアブーツ
- コンフォートパンプス
- コンフォートサンダル
- コス 制服
- コス 巫女
- コス 天使
- コス 体操・チアガール
- コス 囚人
- コス 魔女
- コス 警官
- コス 悪魔
- コス レースクイーン
- コス ファンタジー
- コス ナース
- コス ドクター
- コス チャイナドレス
- コス ゾンビ
- コス セーラー
- コス スクール
- コス サンタクロース
- コス キャビンアテンダント
- コス ウェイトレス
- コス アニマル
- コス アーミー
- コクーンコート
- ゴアードスカート
- キルティングジャケット
- キャバスーツ
- ギャザースカート
- カクテルコート
- ガウチョ・スカーチョ
- オペラシューズ
- オックスフォードシューズ
- オーダーメイドスーツ
- ウエディングドレス
- ウェッジソールサンダル
- アンサンブル
- アオザイ
- ワイドパンツ
- ニット・セーター
- ダウンコート
- タイトスカート
- その他ワンピース
- 浴衣単品
- 着物
- 和服 着物 浴衣
- 和装小物
- その他和服
- コスチューム
- ワンピーススーツ
- パンツスーツ
- その他スーツ
- スカートスーツ
- 水着セット
- 水着インナー
- ワンピース水着
- ラッシュガード
- ビキニ
- タンキニ
- その他水着
- ライダースジャケット
- モッズ ミリタリー
- ポンチョ
- ベスト
- ファー 毛皮
- ノーカラージャケット
- トレンチコート
- デニムジャケット コート
- テーラード ツイードジャケット
- チェスターコート
- ダウンジャケット コート
- その他アウター
- ジャンパー ブルゾン
- Aライン ピーコート
- セットアップ
- ジャンパースカート
- サロペット オールインワン
- コンビネゾン
- ロングスカート
- ミニスカート
- ミディアムスカート
- デニムスカート
- その他スカート
- キュロットスカート
- ロングパンツ
- レギンス
- デニム ジーンズ
- その他パンツ
- ショート ハーフパンツ
- サルエル カーゴパンツ
- クロップド カプリパンツ
- ポロシャツ
- パーカー
- ニット
- チュニック
- スウェット トレーナー
- シャツ ブラウス
- キャミソール タンクトップ
- カーディガン
- Tシャツ カットソー
- ロング マキシ丈/長袖
- ロング マキシ丈/袖なし
- ロング マキシ丈/半袖
- ミニ ひざ丈/長袖
- ミニ ひざ丈/袖なし
- ミニ ひざ丈/半袖
- プリント 柄ワンピ
- ニットワンピ
- ドレス
- デニムワンピ
- その他ワンピース
- シャツワンピ
- シフォン レースワンピ
- キャミ ベアワンピ
- Tシャツワンピ
- 冬服
- 夏服
- 秋服
- 春服
-
Beauty
-
コスメ、美容、ヘアケア
- コンタクトレンズケース 小物
- 泡立て器 ネット
- 脱毛剤 ワックス クリーム
- 目元美容液
- まつげ美容液
- フットクリーム
- フェイスクリーム
- バストケアクリーム ジェル
- ネイルドライヤー
- ネイルチップ
- トリートメント
- ツィザー(毛抜き)
- その他石けん ボディソープ
- その他メンズコスメ
- その他ヘアケア スタイリング
- スプレー
- クレンジング
- お香
- アートブラシ
- コフレ
- オールインワンスキンケア
- クレンジング
- ゴマージュ、ピーリング
- シートマスク
- スキンケアオイル
- スキンケアクリーム
- スキンケアトライアルセット
- その他スキンケア、フェイスケア
- パック
- リップケア、リップクリーム
- 化粧水
- 美容液
- 乳液
- 洗顔
- コフレ
- オールインワンスキンケア
- クレンジング
- ゴマージュ、ピーリング
- シートマスク
- スキンケアオイル
- スキンケアクリーム
- スキンケアトライアルセット
- その他スキンケア、フェイスケア
- パック
- リップケア、リップクリーム
- 化粧水
- 美容液
- 乳液
- 洗顔
- コフレ
- オールインワンスキンケア
- クレンジング
- ゴマージュ、ピーリング
- シートマスク
- スキンケアオイル
- スキンケアクリーム
- スキンケアトライアルセット
- その他スキンケア、フェイスケア
- パック
- リップケア、リップクリーム
- 化粧水
- 美容液
- 乳液
- 洗顔
- メイク・グッズ
-
美容 ダイエット 健康
- フェイス ボディーローラー
- 着圧タイツ トレンカ
- 二の腕シェイパー
- 着圧レギンス スパッツ
- 小顔グッズ
- 美鼻グッズ
- 骨盤ベルト
- サウナスーツ
- 姿勢矯正
- 外反母趾
- 着圧ソックス
- 着圧ストッキング
- 矯正グッズ
- 安眠グッズ
- フットケア用品
- ダイエットウエア・サポーター
- その他抗菌・除菌グッズ
- その他リラックス・マッサージ用品
- その他ダイエット・フィットネス器具
- アイケア用品
- 除毛 脱毛
- 美顔器 フェイスローラー
- その他美容グッズ
- 健康用品/その他
- ダイエットサプリメント
- 矯正用品
- 健康用品
- マッサージ用品
- エクササイズ
- ダイエット用品
- ダイエット器具
- ダイエットジェル パッチ
- ダイエットウェア サポーター
-
ヘア ボディ ネイル 香水
- ネイルシール
- ネイル用コットン
- ネイルリムーバー
- ネイルブラシ
- ネイルファイル
- ネイルアームレスト
- トレーニングハンド
- マニキュアセット
- ウッドスティック
- ネイルケア専門グッズ
- 爪切り
- 爪ブラシ ダストブラシ
- ネイルプッシャー
- ネイルニッパー
- ジェルネイル用ライト
- リムーバー
- ラインストーン
- マニキュア
- ベースコート トップコート
- ネイル関連商品
- ネイルセット ネイルツール
- ネイルケア
- デコパーツ
- ジェルネイル
- キューティクルオイル
- UVライト スターターセット
- 男性用
- 女性用
- ユニセックス
- その他 香水
- ハンドソープ
- ハンドケア関連商品
- ハンドクリーム
- その他 ハンドケア
- ミスト ボディケア
- ボディウォッシュ
- フットケア
- デオドラント
- その他 ボディケア
- スクラブ
- シェービングクリーム
- シェーバー
- クリーム
- オイル
- 男性ヘアケア
- ヘアカラー
- ヘアエッセンス
- ブラシ 櫛
- トリートメント
- その他 ヘアケア
- スタイリング剤
- シャンプー/トリートメント セット
- シャンプー
- コンディショナー
- コスメ
-
コスメ、美容、ヘアケア
-
Kids
-
おもちゃ 知育
- 化粧台 ドレッサー デスク
- 子供用自転車
- 子供三輪車
- その他子供自転車 乗用
- 消しゴム
- はさみ
- ノート
- ステッカー シール
- 言語知育教材
- 天体望遠鏡
- かず 計算
- お絵かき
- 水鉄砲
- 砂あそび
- ラジコン飛行機
- ラジコン船
- ラジコンヘリコプター
- ラジコンバイク
- 飛行機 ヘリコプター
- ミニカー
- ままごと 大工さん
- ままごと お医者さん
- ままごと お店屋さん
- 木製ブロック
- 磁気ブロック
- ナノブロック
- 建築物 情景模型
- 飛行機 ヘリコプター模型
- 船模型
- 車 バイク模型
- ロボット模型
- ロケット 宇宙船模型
- その他 プラモデル 模型
- 知恵の輪
- キャラクターぬいぐるみ
- 男の子 なりきりアイテム ロボット
- 変身グッズ
- ロボット
- スポーツ玩具 竹馬
- スポーツ玩具 ゴルフ
- キックスクーター ボード
- 文房具セット
- ペン
- 知育教材 顕微鏡
- その他パズル
- 子供用パズル
- トラック ブルドーザー
- プラモデル 模型 ミリタリー
- スポーツ玩具 サッカー
- 置物 壁掛け
- 戦闘服
- 天然石グッズ
- 天然石アクセサリー
- 食器類 陶器
- 開運 金運グッズ
- ヨーヨー本体
- ポーチ バッグ
- ヘルメット 帽子
- プログラミングロボット
- ブランコ
- フライト
- フェイスマスク
- ハンドスピナー フィジェットトイ
- ねんど
- ぬりえ
- タロットカード
- ダーツボード
- その他装備 衣料
- その他占い 開運 風水
- その他天然石 パワーストーン
- その他ダーツ
- その他サバイバルゲーム
- その他エアガン トイガン
- スポーツトイ
- すべり台
- スタンプ
- ジャングルジム
- シャフト
- サイト スコープ
- ゴーグル サングラス
- グリップ
- クッキングトイ
- キッズコスメ アクセサリー
- UNO
- 浮き輪
- その他知育玩具・教育玩具
- その他季節行事
- おもちゃその他
- オーナメント
- 積み木 ブロック
- ボールプール
- ベビージム
- Kids その他
- がらがら ラトル
- オルゴールメリー
- おしゃぶり はがため
-
キッズ
- 子供用弁当箱 食器
- 子供用アクセサリー
- その他 キッズ小物
- 男の子用パジャマ、女の子用パジャマ
- 女の子用肌着、男の子用肌着
- 女の子用下着、男の子用下着
- その他 キッズ
- 靴下、タイツ
- 帽子
- 長靴 レインシューズ
- 運動靴
- 通園バッグ
- 上履き
- リュックサック
- ランドセル
- ボストンバッグ キッズ
- プールバッグ
- トートバッグ キッズ
- ショルダーバッグ キッズ
- シューズバッグ
- サンダル、ミュール
- キャリーバッグ キッズ
- カジュアル靴
- ウエストポーチ
- 雨具
- 着物 浴衣
- ボトム
- トップス キッズ
- その他 キッズ
- キャラクター服
- キッズ防寒具
- キッズ手袋
- キッズマフラー
- アウター キッズ
- 男の子ファッション
- 女の子ファッション
-
ベビー マタニティ
- 傘
- 戸口ロック ストッパー
- 腹巻
- フォーマル靴
- ダッフルコート
- スカジャン
- スウェットパンツ
- リュックサック
- マザーバッグ
- パジャマ
- その他出産祝い・内祝い・ギフト
- セーター
- オーバーオール
- 母子手帳ケース
- 妊娠線クリーム
- マタニティ食品
- マザーズバック
- その他 産前 産後小物
- 産後リフォーム用品
- 下着
- マタニティパンツ
- マタニティトップス
- マタニティスカート
- マタニティウェア
- マタニティーレギンス ストッキング
- パジャマ
- その他 マタニティ
- メモリアル 記念品
- ギフトセット
- おむつケーキ
- 鯉のぼり
- 雛人形
- 五月人形
- お食い初め用品
- 歩行器
- その他 ベビーグッズ
- コーナークション
- ゲート
- チャイルドシート
- アクセサリー ベビーシート
- 粉ミルク
- 哺乳瓶
- ベビー食器
- ベビーフード
- その他 衛生用品
- スタイ
- 衛生用品その他
- 歯ブラシ
- ヘルスケア用品
- ベビーローション クリーム
- ベビーヘルスケア
- ベビースキンケア
- ウエットティシュ
- UVケア ベビーパウダー
- 湯上りタオル ガーゼハンカチ
- ベビーソープ シャンプー
- その他 お風呂用品
- おふろのおもちゃ
- その他 抱っ紐
- オムツ
- おしりふき
- スリング
- キャリー 抱っこ紐
- アクセサリー 抱っ紐
- 布団
- 収納
- ベビーベット
- ベビーチェア
- プレイマット
- その他 ベビー
- ベビーカー本体
- アクセサリー ベビー
- 水着 ベビー
- 上下セット
- ワンピース
- ロンパース
- よだれかけ
- ボトムス
- ベビー靴 靴下
- ベビー手袋
- ベビー帽子
- ベビー下着 パジャマ
- トップス
- その他 ベビー服
- スカート
- アフガン(おくるみ)
- アウター
-
おもちゃ 知育
-
Living
-
キッチン、日用品、文具
- 冷温庫
- 食洗機
- レタースケール
- タスキ 腕章
- チャーム
- キッズ用食器
- 醤油 ソース差し
- 包丁スタンド
- まな板立て
- パスタボトル
- キッチンクロス
- エッグスタンド
- フリーザーバッグ
- 子供用弁当箱
- 水切りネット 水切り袋
- 調味料入れセット
- 漬物樽
- 製氷皿
- ホッチキス
- セキュリティケース・ポーチ
- スポンジ
- バス用ブラシ
- パスポートカバー
- その他旅行用品
- マット類
- 整理用トレー
- 爪切り
- 浴槽・浴室内マット
- 油性ペン
- 靴べら
- 携帯用洗浄機
- 携帯容器・ケース
- 洗濯用ハンガー
- 洗面用ブラシ・クシ
- 洗面器・風呂桶
- 物干しスタンド
- 網戸用掃除用品
- 透明テープ
- 天然ゴム手袋
- 水性サインペン
- 水拭きモップ
- 書道用筆
- 手芸用リボン
- 手芸用ファスナー
- 手芸用ひも
- 手提げ袋
- 前詰まりスリッパ
- 綿(無地)
- 綿(柄物)
- 旅行用ポーチ
- 旅行用かばん
- 軍手
- 接着テープ・接着芯
- 付箋紙
- 風呂枕
- 耳かき
- 多機能ペン
- 断熱シート
- 刺繍糸
- 歯ブラシスタンド・ホルダー
- 喫煙パイプ
- 布団圧縮袋
- 布切はさみ
- 便座カバー シート
- レターケース
- リラックスグッズ
- ラッピング用品ボックス
- ラッピング用袋
- ボビン
- ボディタオル
- ポケット式アルバム
- ペンケース
- へアーバンド
- ブレスレット
- ファイル
- バス用排水口フィルター
- トイレ用スリッパ
- ティッシュケース(ボックス用)
- ティッシュケース(ポケットティッシュ用)
- ティーライト
- タオルギフトセット
- その他作業用手袋・軍手
- その他整理用品
- その他災害救助用品
- その他印鑑・ハンコ
- その他修正液・修正ペン・修正テープ
- その他物干し用品
- その他手芸用品
- その他手芸・クラフト・生地
- その他手縫い糸
- その他名札
- その他梱包資材
- その他防災関連グッズ
- その他刺繍
- その他裁縫用針
- その他筆記具
- その他マット類
- その他ボタン
- その他ビーズ
- その他シューズ関連小物
- その他シューズ関連小物
- その他システム手帳
- その他クリップ
- その他カレンダー
- その他アルバム
- その他アクセサリーキット
- スリッパ・ルームシューズセット
- シガレットケース
- コットンパール
- クリアケース・クリアファイル
- かぎ針
- お掃除シート
- お風呂用イス
- うちわ
- アクセサリーパーツ
- カタログギフト
- キッチン、台所用品
- ギフト券(コード販売)
- ギフト券(券、カード販売)
- ゴミ箱、ダストボックス
- スリッパ
- その他キッチン、日用品、文具
- タオル
- トイレ用品
- バス、洗面所用品
- 芳香剤、消臭剤、除湿剤
- 防災、防犯、セーフティ
- 冠婚葬祭、宗教用品
- 掃除用具
- 文具、ステーショナリー
- 蚊取り、防虫、害虫駆除
- 洗濯用品
- アイロン台
- その他洗濯用品
- たらい
- ランドリーバスケット
- 布団たたき
- 布団ばさみ
- 布団干し
- 毛玉取り
- 漂白剤
- 柔軟剤
- 室内物干し
- 物干しハンガー、ピンチ
- 物干し竿、ロープ
- 洗剤
- ギフトセット
- 粉末洗剤
- 固形洗剤
- 液体洗剤
- 洗濯ネット
- 洗濯のり
- 洗濯バサミ
- 洗濯ブラシ
- 洗濯ボール
- 洗濯板
- 洗濯槽クリーナー
- 衣類カバー
- 雨よけカバー、カーテン
- ゴキブリ駆除剤
- その他害虫駆除、虫よけ
- ネズミ駆除剤
- ノミ、ダニ駆除剤
- ハエ、蚊駆除剤
- 虫よけ剤
- 蚊帳
- 衣類用防虫剤
- アルバム
- お道具箱
- カレンダー
- ガチャック
- クリップ
- クリップケース
- ゴムバンド、輪ゴム
- お名前シール、ネームラベル
- ギフトシール
- シール
- シールはがし
- タックインデックス
- ラベルシール
- ラベルプリンター
- しおり
- その他事務用品
- そろばん
- OPPテープ
- クラフトテープ
- セロハンテープ
- その他のり、テープ
- ビニールテープ
- マスキングテープ
- 布テープ
- 両面テープ
- その他ノート、紙製品
- ノート
- メモ帳
- ルーズリーフ
- レポート用紙
- 単語帳、単語カード
- 方眼紙、グラフ用紙
- 付箋
- 下敷き
- 原稿用紙
- のし紙
- ポチ袋
- 不祝儀
- 短冊
- 芳名長
- 色紙
- 賞状用紙
- 祝儀
- のり
- ボンド
- 瞬間接着剤
- カッターナイフ
- カッティングマット
- その他はさみ、カッター
- テープカッター
- はさみ
- ペーパーナイフ
- 裁断機、ディスクカッター
- 家庭用シュレッダー
- 替刃、裁断関連用品
- クラフトパンチ
- パンチラベル
- 穴あけパンチ
- クリアファイル
- クリアホルダー
- クリップボード
- スプリングファイル
- その他ファイル
- パイプ式ファイル
- バインダー
- ハンギングホルダー
- フラットファイル
- プレスファイル
- ボックスファイル
- リフィル
- リング式ファイル
- レールクリアホルダー
- 個別ホルダー
- 名刺整理
- 書類ケース、図面ケース
- 統一伝票ファイル
- フック
- マグネット
- マグネットシート
- 画びょう、ピン
- ブックカバー
- ホッチキス、ステープラー
- OPP袋
- オーナメント
- ギフトシール
- ギフト袋
- ギフト箱
- その他ラッピング用品
- パッキン
- ラッピングセット
- ラッピング用リボン、紐
- 包装紙
- 紙袋
- ラミネーター
- グリーティングカード
- シーリングワックス
- その他レター用品
- ペーパーナイフ
- ポストカード、絵葉書
- レターセット
- 便箋
- 封筒
- 絵手紙、カード紙
- クレヨン
- シャープペンシル本体
- 芯、替えゴム
- 製図用シャープペンシル
- その他筆記用具
- チェックペン用品
- ボールペン
- ボールペン替え芯
- 受付ペン、デスクペン
- ボードマーカー
- マーカー
- 蛍光ペン
- 筆ペン、万年毛筆
- カートリッジ
- 筆ペン
- 万年毛筆
- 筆箱
- 鉛筆
- 鉛筆キャップ、ホルダー
- 鉛筆削り、電動鉛筆削り
- 色鉛筆
- インク
- 替えペン先
- 万年筆
- 消しゴム
- 修正ペン、修正テープ
- 電卓
- コンパス
- その他製図用品
- ブラシ
- 分度器
- 三角スケール
- 三角定規
- 雲形定規
- 直線、方眼定規
- 製図テンプレート
- 製図板
- 製図用シャープペンシル
- 字消し板
- おりがみ
- クロッキーブック
- ケント紙、コート紙
- スケッチブック
- セロファン
- トレーシングペーパー
- ボール紙、厚紙
- 白和紙
- 画仙紙、書道用紙
- 画用紙、水彩用紙
- 絵手紙、カード紙
- 漫画用紙
- 模造紙
- 千代紙、友禅紙
- 色和紙
- 色画用紙
- その他机上アクセサリー
- デスクマット
- ファイルスタンド
- ブックスタンド
- ペーパーウェイト
- レタートレー、デスクトレー
- 地球儀
- 名刺整理用品
- 鉛筆立て、ペン立て
- 名刺
- 名札、番号札
- システム手帳
- システム手帳用リフィル
- その他手帳、日記
- 家計簿
- 日記帳、ダイアリー
- 手帳
- 手帳カバー
- 住所録、電話帳
- スタンプ台、朱肉
- デザインスタンプ
- 補充インク
- 法人印
- 個人印
- 事務印、事務スタンプ
- 印鑑関連用品
- カーボン紙
- チェックライター
- 法令様式、ビジネスフォーム
- 履歴書
- 伝票
- 帳簿
- 指サック、紙めくり
- カードリング
- その他製本、綴じ込み用品
- つづりひも
- つづり込み表紙
- ペーパーファスナー
- メニューブック
- 製本カバー
- 製本キット
- 製本テープ
- 製本機
- 子ども用文具セット
- ガラスワイパー、スクイジー
- ゴミ袋、ポリ袋、レジ袋
- その他掃除用具
- ダスター、クロス
- ちりとり
- デッキブラシ
- トイレブラシ
- パイプ用ブラシ
- バケツ、ポリバケツ
- フロアワイパー
- フロアワックス
- ほうき、はたき
- モップ、雑巾
- モップ絞り器
- 掃除用ブラシ
- 台所用スポンジ、たわし
- エタノール
- ガラス、網戸用洗剤
- サビ取り、金属用洗剤
- その他洗剤
- トイレ洗剤
- フロア用洗剤
- マルチクリーナー
- 防カビ洗剤
- 配管用洗剤
- 水垢用洗剤
- クレンザー
- 漂白剤
- 食器洗い、台所用洗剤
- 食洗器用洗剤
- 洗濯槽クリーナー
- ギフトセット
- 粉末洗剤
- 固形洗剤
- 液体洗剤
- 浴室洗剤
- 重曹、クエン酸
- 浴室用ブラシ、スポンジ
- 粘着クリーナー
- 桟、溝ブラシ
- その他冠婚葬祭、宗教用品
- のし紙
- 不祝儀
- 祝儀
- ふくさ
- メモリアル用品作成グッズ
- ろうそく
- 風呂敷
- その他仏壇、仏具
- りん、りん棒
- 仏具セット
- 仏事用香炉
- 仏壇
- 仏像
- 骨壺、骨袋
- 掛図
- 花立
- 経机
- 具足
- 木魚
- 提灯
- 位牌
- 線香
- 線香立て
- 線香着火器
- プチギフト
- リングピロー
- 白木台
- 結納品
- 席次表、席札
- 演出グッズ
- 招待状
- 祭り用品
- お面
- 法被
- 祭り小道具
- 祭り用衣類
- 神棚、神具
- かがり火
- 燈籠
- 三方
- 神鏡
- 神具セット
- 神棚
- 御霊舎、祖霊舎
- 数珠
- 水引
- その他巡礼、遍路用品
- 白衣
- 金剛杖
- 輪袈裟
- 納経帳
- 納経軸
- 巡礼、遍路セット
- インターホン
- その他防災、防犯、セーフティ
- ブレーカー自動遮断装置
- 避難生活用品
- エマージェンシーシート
- ガイガーカウンタ
- その他避難生活用品
- 備蓄用保存水
- 発熱剤
- 非常用ろうそく
- 非常用持ち出しセット
- 非常用給水袋、タンク
- 非常用食品
- 携帯トイレ
- 携帯用浄水器
- 避難用具
- その他避難器具
- ホイッスル
- マスク
- 避難はしご
- 避難用ロープ
- 担架
- 防災ヘルメット
- 防災頭巾
- 懐中電灯、ライト
- 拡声器、メガホン
- 錠、ロック、かぎ
- 防犯アラーム、センサー
- 防犯カメラ
- 防犯フィルム
- 防犯用カラースプレー、ボール
- 護身用品
- 家具転倒防止用品
- 警報器、ブザー
- 救急箱
- 消火器、消防用品
- 携帯用ブザー
- ゴミ箱用
- その他芳香剤、消臭剤
- トイレ用
- ペット用
- 部屋用
- 除湿、乾燥剤
- シャンプー
- せっけん
- その他バス、洗面所用品
- ディスペンサー、スプレーボトル
- トリートメント、ヘアパック
- バスオイル
- バスグッズ
- バスソルト
- バスローブ
- バブルバス
- ボディソープ
- リンス、コンディショナー
- 入浴剤
- ソープディッシュ
- 歯ブラシ立て
- シャワーカーテン
- シャワーヘッド
- バススリッパ
- バスチェア
- バスマット
- 風呂ふた
- 風呂マット、すのこ
- 排水口カバー、ネット
- 湯桶、手桶
- 吸盤フック
- 浴室、石鹸ラック
- 浴室洗剤
- 浴室用ブラシ、スポンジ
- サニタリーボックス
- その他トイレ用品
- トイレットペーパー
- トイレブラシ
- トイレ洗剤
- トイレ洗浄シート
- トイレ用カバー
- トイレ用ペーパーホルダー
- トイレ用ペーパーホルダーカバー
- トイレ用マット
- トイレ用マット、カバーセット
- トイレ用芳香剤、消臭剤
- ラバーカップ
- 便座シート
- タオル
- その他キッチン、日用品、文具
- スリッパ
- 携帯用スリッパ
- 子供用スリッパ
- ゴミ箱、ダストボックス
- ギフト券(券、カード販売)
- ギフト券(コード販売)
- アルコールグラス
- カクテルシェイカー
- カクテルピン
- スキットル、フラスコ
- バーセット
- ビターズボトル
- マドラー
- メジャーカップ
- グラスマーカー
- ジョッキ
- その他アルコールグッズ
- ビールサーバー
- ラベルアルバム、コレクター
- ソムリエナイフ
- デキャンター
- ポアラー
- ボトルストッパー
- ワインオープナー
- ワインクーラー
- ワインセーバー
- ワインセラー
- ワインバッグ
- ワインラック
- ワイン用温度計
- お猪口、ぐい飲み
- その他日本酒器
- 盃
- 徳利
- 升
- 屠蘇器
- アイスクラッシャー
- アイススコップ
- アイスピック
- アイスペール
- 製氷皿
- エプロン
- 割烹着
- 三角巾
- お盆、トレイ
- キッチンマット
- キッチンラック
- グラスホルダー
- スポンジ、洗剤ラック
- その他収納、ラック
- ふきん掛け
- ラップ、ペーパータオルホルダー
- ワインラック
- 包丁、まな板スタンド
- 調味料ラック
- 食器スタンド
- 吸盤フック
- アルミホイル
- キッチンゴム手袋
- キッチンペーパータオル
- クッキングシート
- ゴミ袋、ポリ袋、レジ袋
- ジップバック
- ストロー
- タコ糸
- バラン
- ふきん、台ふきん
- ワックスペーパー
- 食品用ラップ
- 食器棚シート
- 使い捨ておしぼり
- 脱臭、消臭剤
- 油処理剤
- 爪楊枝、ピック
- 紙ナプキン
- 竹串
- 卓上用固形燃料
- クリーマー
- カップ、ソーサー
- カフェオレボウル
- コーヒータンパー
- コーヒーポット
- コーヒーメジャー
- サイフォン
- デミタスカップ
- ドリッパー
- ドリップポット
- フィルター
- マグカップ
- ミルク泡立て器
- 電動コーヒーミル
- 手動ロースター
- 手挽きコーヒーミル
- 直火式エスプレッソメーカー
- シュガーポット
- その他コーヒー、ティー用品
- ティーウォーマー
- ティーカップ、ソーサー
- ティーコジー、ポットカバー
- ティーサーバー、ティーメーカー
- ティーストレーナー
- ティーポット
- 茶さじ、ティーメジャー
- その他茶器
- 茶こし
- 茶こぼし
- 茶道、お点前セット
- 茶壺、茶入、棗(なつめ)
- 茶筒
- 茶托
- 茶筅
- 釜
- 菓子楊枝
- 懐紙
- 急須
- 抹茶茶碗
- 湯飲み
- 鉄瓶
- 中国茶器
- シンクマット
- レンジカバー、油はねガード
- 換気扇カバー、フィルター
- 排水口用品
- 三角コーナー
- 水切りカゴ
- 洗い桶
- その他キッチン、台所用品
- おしぼりタオル
- おしぼりトレイ
- その他テーブルリネン
- テーブルクロス
- テーブルセンター
- ナプキン
- ナプキンスタンド
- ナプキンリング
- ランチョンマット
- ガラス瓶、キャニスター
- ドレッシングボトル
- バターケース
- ブレッドケース
- 調味料ケース
- 果実酒瓶
- 米びつ
- 食品保存容器
- 漬け物容器
- おかずカップ
- おしぼりケース
- おしぼりタオル
- おにぎりケース
- キャラ弁グッズ
- サンドイッチケース
- バラン
- ピクニックバスケット
- ピック
- ランチクロス
- ランチベルト、バンド
- 保温弁当箱
- 弁当箱
- 弁当用カトラリー
- 使い捨て弁当箱、紙バック
- 水筒
- 水筒カバー、ケース
- 子ども用お弁当袋、ランチバッグ
- 子ども用弁当箱
- 子ども用水筒
- かき氷機
- カセットコンロ
- アイスクリームディッシャー
- オイルポット
- おろし器
- お玉、レードル
- かつ箱、かつお節削り器
- キッチンツールセット
- こし器
- しゃもじ
- シリコンラップ、フタ
- スライサー、カッター
- スライサー、カッター
- スライサー、カッター
- スライサー、カッター
- スライサー、カッター
- すり鉢、すり棒
- その他キッチンツール
- ターナー、フライ返し
- トング
- ハケ
- ペッパーミル
- ヘラ、スパチュラ
- レモン絞り、スクイーザー
- 菜箸
- 鍋つかみ
- 料理バサミ
- 鱗取り
- 落し蓋
- 泡だて器
- 皮むき、ピーラー
- 肉たたき
- 焼き網
- 栓抜き、缶切り、オープナー
- 製氷皿
- ざる、ストレーナー
- バット
- 調理用ボウル
- 水切り、サラダスピナー
- その他調理用具
- うどん、そば道具
- そば、麺切り包丁
- パスタマシン
- まな板
- ケーキナイフ
- その他包丁、ナイフ
- そば、麺切り包丁
- チーズナイフ
- パン切りナイフ
- ぺティナイフ
- 包丁セット
- 薄刃包丁
- 菜切り包丁
- 出刃包丁
- 砥石、シャープナー
- 骨切り包丁
- 柳刃包丁
- 牛刀
- 三徳包丁
- 中華包丁
- 子ども用包丁
- 電子レンジ調理用品
- あられ鍋
- グリルパン
- せいろ、蒸し器
- その他鍋、グリル
- タジン鍋
- ふた
- フライパン
- ヤカン、ケトル
- 保温調理鍋
- 寸胴鍋
- 鍋、フライパンセット
- 鍋敷き
- 圧力鍋
- 両手鍋
- 料理別フライパン
- 料理別鍋
- 落し蓋
- 片手鍋
- 土鍋
- 雪平鍋
- 中華鍋
- キッチンタイマー
- クッキングスケール
- 調理用温度計
- 計量カップ
- 計量スプーン
- 塩分計
- 臼、杵
- 七輪
- 型抜き、料理型
- オーブントレー、シートパン
- クープナイフ、ベーカーズナイフ
- ケーキサーバー
- ケーキナイフ
- スクレイパー
- その他製菓、製パン用品
- のし台
- パレットナイフ
- パンマット、布
- ふるい
- ベイキングカップ
- めん棒
- ラッピング、ケーキ箱
- ワックスペーパー
- 和菓子製菓用品
- 回転台
- 絞り袋
- 口金
- 泡だて器
- 洋菓子型、パン型
- 製菓用こし器
- 製菓用デコレーション
- アルカリイオン整水器
- ビルトイン浄水器
- ポット型浄水器
- 浄水器カートリッジ
- 浄水器部品、アクセサリー
- 蛇口用浄水器
- カトラリーセット
- カトラリーレスト
- ケーキサーバー
- サラダトング
- スプーン
- その他カトラリー、箸
- テーブルナイフ
- ピック
- フォーク
- レンゲ
- 菓子楊枝
- 箸
- 箸置き
- コースター
- カップ、ソーサー
- カフェオレボウル
- クリーマー
- コーヒーポット
- シュガーポット
- その他コーヒー、ティーカップ
- ティーカップ、ソーサー
- ティーポット
- デミタスカップ
- マグカップ
- アルコールグラス
- お猪口、ぐい飲み
- コップ、グラス
- ジョッキ
- その他日本酒器
- 盃
- 徳利
- 升
- 屠蘇器
- その他食器、カトラリー
- タンブラー
- マドラー
- その他茶器
- 茶こし
- 茶こぼし
- 茶筒
- 茶托
- 急須
- 抹茶茶碗
- 湯飲み
- 鉄瓶
- 魔法瓶ポット
- おひつ
- ケーキスタンド
- スープカップ
- そば用食器
- デザート椀、サンデーカップ
- とんすい
- 鉢、ボウル
- 飯碗
- 蓋つき煮物椀
- 菓器、菓子入れ
- 醤油さし、卓上調味料入れ
- 丼
- 皿
- 食器セット
- 寿司桶
- 汁椀
- 重箱
- インサートカップ
- カップホルダー
- コップ
- スプーン
- その他使い捨て食器
- フォーク
- マドラー
- 割り箸
- 皿、ボウル
- 水差し、ピッチャー
- お子様プレート、皿
- コップ
- コップ袋
- スプーン、フォーク
- その他子ども用食器
- 茶碗
- 食器セット
- 箸
- キッチン用除菌剤
- クレンザー
- スポンジ、たわし
- その他洗浄用品
- ぬめり取り
- 漂白剤
- 食洗器用洗剤
- 台所用洗剤
-
家電
- ホームシアターシステム
- その他スマホ
- 電子たばこ本体
- 温浴器
- 脱毛器付属品・消耗品・アクセサリ
- 体組成 体脂肪計
- 体重計
- 石油ストーブ
- 掃除機付属品・消耗品・アクセサリ
- 掃除機
- 掃除機
- 全自動洗濯機付属品・消耗品・アクセサリ
- 乾電池
- 暖房機器
- 毛穴スキンケア家電
- 空気清浄機付属品・消耗品・アクセサリ
- 浄水器
- 禁煙グッズ
- 家庭用プラネタリウム
- 加湿器付属品・消耗品・アクセサリ
- 高圧洗浄機付属品・消耗品・アクセサリ
- 高圧洗浄機
- 多機能ラジオ
- 電子たばこ付属品・消耗品・アクセサリ
- 電子ケトル
- 電源タップ・延長コード
- 電話機付属品・消耗品・アクセサリ
- 歯ブラシ除菌器
- 歩数計
- 布団クリーナー
- 壁掛け扇風機
- ロボット型掃除機付属品・消耗品・アクセサリ
- ロボット型掃除機
- レコードプレイヤー本体
- リビング扇風機
- マスク
- ブラックライト
- フットマッサージャー
- ハンディマッサージャー
- なわとび
- トレーニングベンチ
- トルマリンアクセサリー
- トイカメラ
- テレビ用壁掛け金具
- テレビ用リモコン
- チューブ
- チューナー
- チタンアクセサリー
- ダンベル
- タブレットPCバッグ
- ダイエットティー
- ダイエットスリッパ
- ダイエットクッション
- その他映像プレイヤー レコーダー
- その他蛍光灯・電球
- その他携帯電話用アクセサリー
- その他脱毛器
- その他扇風機
- その他掃除機・クリーナー
- その他空気清浄機
- その他加湿器
- その他計測器 健康管理
- その他電子書籍リーダーアクセサリー
- その他電子たばこ
- その他電池延長コード
- その他磁気 機能性アクセサリー
- その他ラジオ
- その他ミシン
- その他マッサージ機
- その他ボディシェーバー
- その他ポータブルオーディオ
- その他ヘッドホン イヤホンアクセサリー
- その他ヘッドホン イヤホン
- その他ヘッドホン
- その他フェイスケア家電
- その他バッテリー 充電器
- その他テレビ周辺機器
- その他ダイエットドリンク
- その他スピーカー
- その他ウェアラブルデバイス
- その他イヤホン
- セルカ棒
- ゼリー系
- スマホリング
- スマホスタンド
- スマホ タブレット用充電器
- スプレー
- スピーカー本体
- ストレッチグッズ
- スチームクリーナー付属品・消耗品・アクセサリ
- サーキュレーター
- クリップ扇風機
- イヤーチップ
- SIMカード タブレットセット
- LED電球
- EMS
- AVアンプ AVレシーバー
- 電動歯ブラシ
- 口腔洗浄機
- その他美容家電
- カールドライヤー
- その他ヘアケア、頭皮ケア
- ヘアアイロン
- ヘアドライヤー
- ホットカーラー
- 海外用ドライヤー
- 頭皮エステ、マッサージャー
- スチーマー
- その他ボディ、フェイスケア
- ネイルポリッシャー
- ホットビューラー
- 除毛、脱毛器
- 美顔器
- 目もとエステ、マッサージャー
- ヒゲトリマー
- 電気バリカン
- 耳、鼻毛カッター
- 眉毛、フェイスシェーバー
- メンズシェーバー
- メンズシェーバー替刃、アクセサリー
- ボディシェーバー
- レディースシェーバー替刃、アクセサリー
- 眉毛、フェイスシェーバー
- 充電式、電源式あんか
- 除湿機
- 除湿機部品、アクセサリー
- 電気毛布、ひざ掛け
- 加湿器
- 加湿器フィルター
- 加湿器部品、アクセサリー
- イオン発生器
- 空気清浄機
- 空気清浄機部品、アクセサリー
- 空気清浄機交換フィルター
- 脱臭機、消臭機
- 扇風機、サーキュレータ
- 扇風機部品、アクセサリー
- 足温器、フットバス
- 除湿機
- 電子ドラム・電子ドラムセット
- マイク
- その他家電
- その他ペット・ペットグッズ
- 卓上扇風機
- 衣類乾燥機本体
- 脱毛器本体
- 冷風扇
- 空気清浄機本体
- 加湿器本体
- 付属品・消耗品・アクセサリ
- 電子メモ
- 電気ファンヒーター
- 電動ミシン
- ミキサー
- マッサージクッション
- ヘアドライヤー
- ヘアアイロン
- ハンディクリーナー本体
- パネルヒーター
- その他洗濯機
- その他暖房器具
- その他キッチン家電
- セラミックヒーター
- くつ乾燥機
- 花・ガーデン・DIY工具
-
寝具 ベッド マットレス
- マッサージベッド
- 子供用ベッド
- 振り子時計
- 枕カバー
- 折りたたみチェア
- 温湿時計
- 書類収納
- 室内イルミネーション ネオン
- 人感センサー
- 屏風
- 和風照明
- リフティングテーブル
- ポットワゴン
- フロアスタンド
- テーブルランナー
- その他時計
- その他オフィス収納
- その他インテリア 寝具
- スタッキングチェア
- シンクサイドラック
- コンセントプレート スイッチプレート
- コーヒーテーブル
- クランプ
- クッションチェア
- キルトケット
- エクステンションテーブル
- 折り畳みベッド
- マットレス
- ベッド
- ソファベッド
- すのこベッド
- 2段 3段ベッド
- 枕
- 抱き枕
- 涼感 クール敷パッド
- 敷パッド
- 布団カバー
- シーツ
- 毛布
- 着る毛布
- 春夏向け ケット類
- ブランケット
- 敷き布団
- 掛け布団
- 布団セット
- 子供用布団
- こたつ布団
-
日用品雑貨
- ラップタオル・巻きタオル
- ミニタオル
- ハンドタオル
- スポーツタオル
- 腕時計用ワインディングマシーン
- 腕時計収納ケース・BOX
- 衣料収納具
- 携帯灰皿
- 洗濯ネット
- 手帳
- 南京錠
- 旅行用変圧器・変換プラグ
- 空気枕
- 懐中電灯
- 防犯ブザー・アラーム
- 超音波発生機
- 捕獲・誘引器
- リラックスグッズ
- ポーチ
- その他防犯関連グッズ
- その他トイレ用品
- ソープディスペンサー
- シューキーパー
- インソール
- 洗い桶
- ワインオープナー
- ミトン・鍋つかみ
- コーヒードリッパー
- キッチンスケール
- その他タオル
- 物干し
- 洗濯用品その他
- 衣類ハンガー
- トイレ用品その他
- トイレ用品
- トイレマット Toilet mat
- 掃除道具
- 掃除用品その他
- 生活クーポン
- 非常食
- 防犯カメラ
- 防災セット
- 防災 防犯用品その他
- 簡易トイレ
- お水
- ギフト券
- 裁縫道具
- その他手芸クラフト用品
- 介護用品
- 介護用おむつ
- ベッド関連用品
- その他 介護用品
- 避妊具
- 身だしなみ用品
- 生理用品
- 消毒 殺菌
- 救急用品
- マスク
- 歯磨き粉
- 歯ブラシ 用具
- ホワイトニング関連用品
- その他 デンタルケア
- 髭剃り トリマー
- 石鹸
- 洗顔用品
- 入浴剤
- リンス
- ボディソープ
- フェイスタオル
- バスマット
- バスタオル
- バスグッズ
- その他 バス用品
- シャンプー shampoo
- 除湿剤
- 消臭剤 芳香剤
- 洗濯洗剤
- 柔軟剤
- 住居用洗剤
- フィルター
- バス用洗剤
- トイレ用洗剤
- トイレットペーパー
- ティッシュペーパー
- その他 生活用品
- キッチン用洗剤
- キッチン用ペーパータオル
- 雨具 あまぐ
- 虫よけ剤 スプレー
- 湯たんぽ カイロ
- 旅行用品
- 夏用品
- 収納用品
- 冬用品
- 傘
- レインコート
- その他 生活雑貨
- スリッパ ルームシューズ
- ギフト イベントグッズ
- エプロン
- アロマオイル
- アイディア商品
-
家具 インテリア
- パソコンデスク
- おもちゃ収納
- カーペット、マット
- ソファ
- チェスト
- テーブル
- システムベッド
- ベビーベッド
- 二段ベッド
- 三段ベッド
- ポールハンガー
- ラック、ランドセル収納
- 絵本ラック、本棚
- シーツ、敷きパッド、カバー
- タオルケット
- 布団セット
- 敷き布団
- 掛け布団
- 毛布、ブランケット
- 枕、ピロー
- 学習机
- 学習机用ワゴン、ラック
- 子供用学習机付属品、パーツ
- 学習椅子、キッズチェア
- クリップライト
- シーリングファン
- シーリングライト
- シャンデリア
- スポットライト
- その他天井照明、シーリングライト
- ダウンライト
- ベースライト
- ペンダントライト
- その他照明器具
- フットライト、足元灯
- ブラケットライト、壁掛け灯
- フロアライト
- HIDランプ
- LED電球、LED蛍光灯
- 白熱電球
- 点灯管、グローランプ
- 蛍光灯
- スイッチカバー
- ソケット
- その他照明部品
- ライティングレール
- ランプシェード
- リモコン
- 調光器、調光スイッチ
- 人感、明暗センサー
- 引掛けシーリング
- その他卓上スタンドライト
- テーブルライト
- デスクライト
- オットマン、足置き台
- オフィス、ワークチェア
- カウンターチェア
- キッズチェア、学習椅子
- シェーズロング、寝椅子
- スツール
- その他椅子、スツール、座椅子
- ダイニングチェア
- チェア用床保護マット
- パーソナルチェア
- バランスチェア
- ハンギングチェア
- ベビーチェア
- ベンチ
- マッサージチェア
- ロッキングチェア
- 椅子付属品、パーツ
- 正座椅子
- 座椅子、高座椅子
- スリッパラック、スタンド
- 傘立て
- 下駄箱、シューズボックス
- 玄関ベンチ
- 玄関台、玄関踏み台
- カバー、シーツセット
- フラットシーツ
- ベッドカバー
- ベッドスカート
- マットレスカバー
- 除湿シート
- トイレ収納
- ランドリー収納
- 洗濯機ラック
- ウォールシェルフ
- オープンシェルフ
- カラー、キューブボックス
- スチールラック本体
- スチールラック部品
- その他収納ラック
- マガジンラック
- ラック用付属品、パーツ
- 本棚、書棚
- 壁面システム収納
- 突っ張りラック
- 卓上本棚、ラック
- スタンドミラー、姿見
- その他ミラー、ドレッサー
- ドレッサー、鏡台
- 壁掛け鏡、ウォールミラー
- 卓上ミラー
- その他ベッド、マットレス
- システムベッド
- すのこベッド
- フレーム、マットレスセット
- ベッドフレーム
- ベビーベッド
- ロフトベッド
- 二段ベッド
- 脚付きマットレスベッド
- 介護ベッド
- 三段ベッド
- 折りたたみベッド
- ベッドガード
- マッサージ台、業務用ベッド
- エアーマットレス、エアーベッド
- スプリングマットレス
- ノンスプリングマットレス
- 天蓋、キャノピー
- すのこ
- 圧縮袋、収納袋
- 収納ケース
- 押入れラック
- その他ファブリック、カバー類
- ソファカバー
- ピアノカバー
- ベッドカバー、スプレッド
- マルチカバー
- 椅子カバー
- 座椅子カバー
- パーテーション、衝立パーテーション、衝立
- ガラスケース
- キャビネット、サイドボード
- テレビ台、ローボード
- 電話台、FAX台
- その他デスク、机
- デスク、机用付属品、パーツ
- デスク用ワゴン、ラック
- フリーデスク、平机
- 書斎机、ユニットデスク
- 文机
- カウンター、ハイテーブル
- コンソールテーブル
- サイドテーブル
- センターテーブル
- その他テーブル
- ダイニングチェア
- ダイニングテーブル
- ダイニングテーブルセット
- テーブル、デスクマット
- テーブル付属品、パーツ
- ナイトテーブル
- マントルピース
- 座卓、ちゃぶ台
- クローゼット、ワードローブ
- コートハンガー
- チェスト、タンス
- ハンガーラック
- 収納ケース
- オットマン
- オフィス用ロビーチェア
- オフィス用応接ソファ
- シェーズロング、寝椅子
- ソファ
- ソファベッド
- ソファ付属品、パーツ
- こたつテーブル
- こたつテーブルセット
- こたつヒーター単体
- こたつカバー
- こたつ布団セット
- こたつ敷き布団
- こたつ掛け布団、上掛け
- 掘りごたつ用カーペット
- こたつ部品、アクセサリー
- デスクこたつ、一人用こたつ
- クッション
- クッションカバー
- ゴロ寝ロングクッション
- その他クッション、座布団
- ヌードクッション
- ヌード座布団
- フロア、ビッグクッション
- マッサージクッション
- 背当て、腰当てクッション
- 骨盤、姿勢矯正クッション
- 授乳クッション
- 椅子用クッション、パッド
- 円座クッション
- 座布団
- 座布団カバー
- キッチンカウンター
- キッチンラック
- キッチンワゴン
- ワインセラー
- 食器棚、レンジ台
- 野菜ストッカー
- ウッドカーペット
- カーペット、ラグ
- クッションフロア
- ジョイントマット
- その他カーペット、ラグ、マット
- タイル、パネルカーペット
- キッチンマット
- チェア用床保護マット
- 階段マット
- 廊下用マット
- 室内用玄関マット
- 屋外用ドアマット
- 敷きもの補助用品
- 掘りごたつ用カーペット
- 置き畳、システム畳
- アコーディオンカーテン
- カフェカーテン
- ドレープカーテン
- レースカーテン
- 裏地カーテン、ライナー
- カーテンレール、ポール
- カーテン付属品、パーツ
- シェード、ローマンシェード
- シャワーカーテン
- すだれ
- その他カーテン、ブラインド、レール
- のれん
- パネルドア
- ブラインド
- プリーツスクリーン
- ホルダー、タッセル、トリム
- ロールスクリーン
- テーブルチェアセット
- テーブル付属品、パーツ
- ワークテーブル、作業台
- オフィス、ワークチェア
- オフィスチェア用台車
- オフィス用スツール
- その他オフィスチェア
- チェア付属品、パーツ
- パイプ椅子
- ロビーチェア
- 会議、ミーティングチェア
- オフィスデスク
- デスク、チェアセット
- オフィスパーテーション、間仕切りオフィスパーテーション、間仕切り
- ファイルワゴン
- プリンターワゴン
- ワゴン、ラック
- 脇机
- オープンラック、物品棚
- オフィスロッカー
- キャビネット、書庫
- シューズロッカー、下駄箱
- ショーケース
- その他オフィス収納
- パソコンラック
- メールボックス
- 保管庫
- 掃除用ロッカー
- 書類、小物整理ケース
- 雑誌、新聞ラック
- その他オフィス家具
- オフィスデスクマット
- デスクトップパネル
- 机上ラック
- ボード付属品、パーツ
- ホワイトボード
- 黒板、電子黒板
- 店舗、商業施設家具
- 工場、物流施設家具
- 教育施設家具
- キーボックス
- コインカウンター
- キャッシュボックス、手提げ金庫
- 金庫
- 金庫付属品、パーツ
- 紙幣計数機
- エントランスマット
- その他応接セット
- プランターボックス
- ロビーチェア
- 案内板、掲示板
- 灰皿、喫煙台
- 記載台
- 傘ぽん、カサ袋スタンド
- 受付カウンター
- 業務用傘立て
- 応接セット
- 応接ソファ
- 応接用テーブル
- 研究施設家具
- 医療福祉施設家具
- イカット
- ウォールステッカー
- ガーランド
- ジェルステッカー
- タペストリー
- ピクチャーレール
- ファブリックパネル
- レリーフ、アート
- オイルランプ
- オブジェ、置き物
- オルゴール
- ガーランド
- キャンドルホルダー
- ゴミ箱、ダストボックス
- サンキャッチャー
- その他インテリア雑貨、小物
- ティッシュケース
- デジタルフォトフレーム
- ポスターフレーム
- 写真立て、フォトフレーム
- ドアストッパー
- モビール
- 風鈴、ウィンドウチャイム
- 花瓶、花器
- 花瓶台、フラワースタンド
- 火鉢
- アクセサリーケース
- インテリアトレイ
- ウォールフック
- ウォールポケット
- かご、バスケット
- ケーブルボックス
- コレクションボックス
- 小物収納、小物入れ
- 新聞ストッカー
- その他インテリア時計
- 掛け時計、壁掛け時計
- 目覚まし時計
- 砂時計
- 置き時計
- 卓上ミラー
- 置き時計
- 枕
- 目覚まし時計
- 掛け時計
- ベースタイプ
- テーブルスタンド
- その他本・CD・DVD収納
- 置時計
- 窓ガラスフィルム
- 突っ張り 棒 棚
- 掛時計
- 壁紙
- 収納ボックス
- テーブルクロス
- その他 インテリア
- ゴミ箱
- ウォールステッカー
- インテリア雑貨
- インテリア照明 ライト
- アンティーク
- 机
- 事務用家具
- ロッカー 棚
- その他 事務器
- オフィスチェア
- 座布団
- ブラインド
- のれん
- ソファーカバー/マット
- クッション
- カーテン
- 卓上収納
- ポール
- ハンガー
- つくえ
- おままごと
- おかたずけ 棚 BOX
- いす
- 玄関マット
- ラグマット ラグ
- トイレマット
- カーペット 絨毯
- ローボード
- テレビ台
- その他家具
- 鏡 ミラー
- ドレッサー
- アクセサリー ケース スタンド
- 食器棚
- 水回り収納
- 台所収納
- レンジ台
- すきま収納
- キッチンワゴン
- 棚
- 本棚
- 押入れ
- ラック
- シューズラック
- ハンガーラック
- チェスト
- クローゼットタイプ収納
- 机 デスク
- テーブル
- サイドテーブル
- こたつ本体
- こたつセット
- 椅子 チェア
- 座椅子
- ソファ
- スツール
-
Sports
- ウォーキングマシン
- トランポリン
- ランニングマシン
- 振動マシン
- バスケットゴール
- トレッキング用品
- 自転車パーツ バーエンド
- 矢筒
- 泥除け フェンダー
- 泥除け フェンダー
- 弓付属品
- バックネット 防球フェンス
- ハイドレーションバッグ アクセサリー
- トレーニングボール
- トレーニングバイク マシーン付属品
- トレーニングバイク マシーン
- トラック フィールド用品
- トラック フィールド用備品
- ディスプレイスタンド
- チェーンステーガード
- チェーン
- その他自転車メンテナンス用品
- その他防犯アクセサリ
- その他プロテクター ヘルメット
- その他バッティング練習機器
- その他カヌー カヤック
- その他ウィンドサーフィン
- ソックス
- セームタオル
- スライディングパンツ
- スマートフォンホルダー
- スプロケット
- スイミングゴーグル
- スイミングキャップ
- オイル
- オイル
- ウエア
- ウォームアップウエア
- シャツ
- ソックス
- パンツ
- シューズ
- その他卓球用品
- シューズケース
- その他バッグ、ケース
- ボールケース
- ラケットケース
- ボール
- シェークハンド
- ペンホルダー
- ラバー
- 設備、備品
- 卓球台
- アンダーシャツ
- コート、ジャケット
- スライディングパンツ
- ソックス、ストッキング
- その他野球ウエア
- ベルト
- ユニフォーム(練習着)
- リストバンド
- 野球帽
- キャッチャーマスク
- キャッチャー用プロテクター
- キャッチャー用ヘルメット
- スロートガード
- レガース
- オイル、手入れ用品
- その他グローブ
- その他グローブ用品
- 軟式
- 硬式
- サポーター、アイシング
- スパイク
- スパイク、シューズ用品
- トレーニングシューズ
- その他野球用品
- エルボーガード
- その他
- フットガード
- ヘルメット
- その他バット用品
- トレーニングバット
- ノックバット
- 軟式
- 硬式
- その他ボール
- 軟式
- 硬式
- スコアボード
- その他野球設備、備品
- ピッチャープレート
- ホームベース、ベース
- ロジン
- 野球スコアブック
- 野球トンボ
- その他野球審判用具
- 審判用ウエア
- 審判用シューズ
- 審判用防具
- 審判用帽子
- その他野球手袋
- バッティング用手袋
- 守備用手袋
- その他練習用具
- トスマシン
- バッティングゲージ
- バッティングティー
- バッティングネット
- ピッチングマシン
- 防球ネット、フェンス
- スパイク、シューズケース
- その他野球バッグ、ケース
- バットケース
- ヘルメットケース
- ボールケース
- 遠征バッグ
- キャップ、被り物
- その他関連グッズ
- タオル
- メガホン
- レプリカユニフォーム
- クラブ
- ジムシャツ、ジムパンツ
- その他器械体操用品
- その他新体操用品
- ハーフシューズ
- フープ
- ボール
- リボン
- ロープ
- 器械体操ウエア
- 器械体操プロテクター
- 器械体操レオタード
- 体操シューズ
- 新体操ウエア
- 新体操レオタード
- カンフー、拳法
- その他格闘技
- ウエア
- キックミット
- グローブ
- サポーター
- サンドバック
- シューズ
- その他ボクシング用品
- パンチングボール
- パンチングミット
- バンテージ
- ヘッドギア
- マウスピース
- 設備、備品
- 合気道
- ケア用品
- その他剣道用品
- 垂
- 胴
- 防具セット
- 防具袋
- その他
- 剣道着
- 袴
- 面
- 木刀
- 設備、備品
- 小手
- 竹刀
- 竹刀袋
- ケア用品
- その他居合道用品
- 居合刀
- 設備、備品
- 衣服
- その他空手用品
- その他
- 帯
- 胴衣セット
- 上胴衣
- 下胴衣
- 防具
- 武具
- その他柔道用品
- 帯
- 柔道衣ズボン
- 柔道衣上衣
- 上下セット
- 設備、備品
- その他相撲用品
- マット
- まわし
- その他薙刀用品
- 防具
- 設備、備品
- 薙刀
- 薙刀衣
- エバーマット
- グランドマーク
- ゴールテープ
- コーン、コーナーポイント
- スターティングブロック
- ストップウォッチ
- スポーツ安全用品
- ゼッケン、タスキ、鉢巻
- その他体育器具
- とび箱
- ハードル
- バトン
- ホイッスル
- ポンプ、コンプレッサー
- ラインテープ
- ライン引き
- ロープ
- ロープリール
- スポーツタイマー
- その他体力測定器
- 背筋力計
- 前屈測定器
- 握力計
- その他記念品
- トロフィー
- メダル
- 盾、モニュメント
- 巻尺
- 拡声器
- 平均台
- 旗
- 踏切板
- 体育マット、シート
- 鉄棒
- 信号器
- 指揮台
- アクアミット
- トレーニングフィン
- パドル
- ビート板
- プルブイ
- コースロープ
- その他設備、備品
- プールカバー
- フロアー
- 残留塩素計
- 掃除用ネット
- 収納カゴ
- 水温計
- 洗浄機
- グローブ、手袋
- スパイク、シューズ
- スポーツサングラス
- ソックス
- その他陸上競技用品
- その他陸上競技用具
- ハンマー投げ
- やり投げ
- 砲丸投げ
- 円盤投げ
- 走り高跳び、棒高跳び
- 陸上用シャツ
- 陸上用パンツ
- ウォームアップウエア
- ストッキング
- ラガーシャツ
- ラガーパンツ
- サポーター
- シューズ
- その他ラグビー用品
- プロテクター
- ヘッドギア
- ラグビーボール
- 設備、備品
- インナーウエア
- セイル
- その他アクセサリー
- ハーネス
- ブーム
- ボード
- マスト
- ライン
- アクセサリー
- ウェイクボード用バッグ
- グローブ
- その他ウェイクボード
- ハンドル、ライン
- ビンディング
- ブーツ
- ボード
- シーガル
- ショートジョン
- スプリング
- その他ウエットスーツ
- タッパー
- ドライ、セミドライスーツ
- フルスーツ
- ベスト
- ロングジョン
- ロングスリーブスプリング
- ショートボード
- その他サーフボード
- ファンボード
- ロングボード
- サーフボードアクセサリー
- サーフボードケース
- サーフボードフィン
- サーフボードリーシュコード
- アクセサリー
- パドル
- ボード
- リーシュコード
- デッキパッド
- ボディボード
- ボディボードアクセサリー
- ボディボードケース
- ボディボードフィン
- ボディボードリーシュコード
- アームウォーマー、アームカバー
- アームバンド
- スポーツサングラス
- その他アクセサリー
- ネックウォーマー、ネッククーラー
- ボトルポーチ
- 手袋
- アウター、ウインドブレーカー
- シャツ
- スカート
- ソックス
- タイツ
- チュニック、ドレス
- パンツ
- 下着
- キャップ
- ジュニア
- メンズ
- レディース
- その他ランニング用品
- アームポーチ
- ウエストポーチ
- キャメルバッグ
- その他バッグ
- バックパック
- ボトルポーチ
- ランニングウォッチ
- ダンベル、鉄アレイ
- ダンベルシャフト
- トレーニング、パワーベルト
- トレーニングベンチ
- バーベル
- バーベルシャフト
- バーベルラック
- パワーグリップ、グローブ
- プッシュアップバー
- フラットベンチ
- エキスパンダー
- エクササイズマット
- シットアップベンチ
- トレーニングチューブ
- トレーニングラダー
- バランスクッション
- バランスボール
- ハンドグリップ
- その他トレーニング用品
- フィットネスメンズ
- フィットネスレディース
- カゼインプロテイン
- ソイプロテイン
- その他プロテイン
- ホエイプロテイン
- その他バレーボール用品
- バレーボール用サポーター
- バレーボール用バッグ
- ボール
- 設備、備品
- その他バスケ用品
- シューズケース
- バッグ、リュック
- ボールバッグ
- ファングッズ
- ボール
- ゴール
- その他練習用具、備品
- ビブス
- 作戦ボード
- 軟式、ソフトテニス
- 硬式テニス
- グリップテープ
- シューズ
- その他テニス用品
- テニス用品小物
- テニス指用サポーター
- シューズケース
- その他テニスバッグ
- バックパック
- ラケットバッグ
- その他ボール
- 軟式、ソフトテニス
- 硬式
- その他ラケット
- 軟式、ソフトテニス
- 硬式
- 練習用具
- キャップ
- サンバイザー
- ガット張り機
- その他
- ネット
- 支柱
- その他小道具
- 舞扇子
- 舞踊傘
- 踊り衣装、着物
- アクセサリー
- スケート靴
- その他スケート用品
- バッグ
- アイスホッケー靴
- スティック
- その他アイスホッケー用品
- パック
- ヘルメット
- ユニフォーム
- アクセサリー
- ウォームアップウエア
- キャップ
- グローブ
- シャツ
- ショルダーパッド
- スパイク
- ソックス
- その他アメフト用品
- パンツ
- ヘルメット
- ボール
- レプリカユニフォーム
- 記念グッズ
- クラブ
- その他グランドゴルフ用品
- ボール
- カイト、凧
- スポーツカイト
- その他スカイスポーツ用品
- ブーメラン
- フリスビー
- アクセサリー
- ウエア
- シューズ
- スカッシュアイガード
- その他スカッシュ用品
- ボール
- ラケット
- その他
- アクセサリー
- ゲート
- ゴールポール
- スティック
- その他
- ボール
- アクセサリー
- ウエア
- シューズ
- その他ドッジボール用品
- ボール
- クラブ
- その他パークゴルフ用品
- ボール
- アクセサリー
- ゴール
- シャツ
- シューズ
- その他ハンドボール用品
- パンツ
- ボール
- ウエア、シャツ
- グローブ、リスタイ
- シューズ
- その他アクセサリー
- フィッティングテープ
- ボウリング用バッグ
- ボール
- ボールクリーナー
- スティック
- その他ホッケー用品
- ボール
- ウエア
- クロス
- ゴールネット
- その他ラクロス用品
- キュロット
- ジャケット
- シャツ
- ズボン
- ソックス
- その他乗馬用品
- ブーツ
- ベルト
- 鞍
- 鐙
- 頭絡
- ウエア
- シューズ
- その他綱引き用品
- 綱引き用ロープ
- 設備、備品
- エナメルバッグ
- シューズケース
- その他スポーツバッグ
- デイパック
- トートバッグ
- ドラムバッグ
- ボストンバッグ
- その他の部位用
- 肩用
- 手首用
- 首用
- 膝用
- 腰用
- 指用
- 肘用
- 足首用
- テーピング
- スポーツサングラス
- スポーツサングラスケース、用品
- スポーツネックレス
- スポーツメガネ
- ステッカー
- その他アクセサリー
- デッキパッド
- ネックウォーマー
- パスケース
- フェイスマスク
- リーシュコード
- インナーウエア
- ジャケット
- シャツ、パーカー
- ソックス
- パンツ
- ワンピース、オールインワン
- 上下セット
- グローブ
- ゴーグル、サングラス
- その他スノーボード用品
- バインディング
- ソールカバー
- その他スノーボードバッグ
- ダッフルバッグ
- バックパック
- ボードケース
- ブーツ
- プロテクター
- ヘルメット
- ボード
- ボードセット
- アイロン
- エッジシャープナー
- コルク
- スクレーパー
- その他メンテナンス用品
- ブラシ
- リムーバー
- ワックス
- ワックススタンド
- 帽子
- 自転車用バッグ
- 自立タープ
- 椅子
- 帽子
- 荷台・キャリア
- 封筒型シュラフ
- レディースシューズ
- ミラー
- マット
- ボクシンググローブ
- ヘッドライト
- フォームローラー
- フィッシュグリップ・魚つかみ
- ハンモック・トイモック
- パドル・オール
- バケツ
- テーブル
- チヌ・石鯛リール
- その他自転車パーツ
- その他キッチンツール(アウトドア)
- その他アウトドア
- スノーゴーグル
- シュノーケル
- サポーター
- サドル
- サイクルコンピューター本体
- サイクルウェア
- グローブ
- クーラーボックス
- キックミット
- ウエストポーチ
- ウィンターウェア
- アイゼン
- アームポーチ
- ヨガマット
- フィットネスマシン
- フィットネスウエア ボトムス
- フィットネスウエア トップス
- その他 フィットネス ヨガ
- フィットネス器具
- シューズ
- 陸上 ジョギング マラソン
- 格闘技
- 卓球
- 体操
- バドミントン
- テニス
- ダンス
- その他スポーツ
- ストリート系スポーツ
- 野球
- ボウリング
- バレーボール
- バスケットボール
- ソフトボール
- その他球技スポーツ
- サッカー
- ラウンド用品 小物
- ボール
- ヘッドカバー
- バッグ ケース
- トレーニング用具
- その他 スポーツ
- その他 ゴルフ用品
- シューズ スポーツ
- ゴルフ用品 小物
- グローブ
- クラブ
- ウェア
- 競技水着
- ラッシュガード スポーツ
- ライフジャケット
- マリンスポーツ用品
- フィットネス水着
- ダイビング シュノーケリング
- その他水着 スポーツ
- スイムキャップ
- ゴーグル
- レディーススポーツウェア
- レディーススポーツインナー
- メンズスポーツウェア
- メンズスポーツインナー
- レディーススポーツシューズ
- メンズスポーツシューズ
- スポーツ用品
- スポーツ帽子
- スポーツバッグ
- スポーツグラス ゴーグル
- アクセサリー
-
キッチン、日用品、文具
-
Digital
- パソコン・PC周辺機器
- テレビ、オーディオ、カメラ
-
タブレット、パソコン
- 望遠鏡本体
- 双眼鏡本体
- ポータブルCDプレイヤー
- ヘッドホンスタンド・ハンガー
- デジタルオーディオプレイヤー
- その他カメラ用周辺機器・アクセサリー
- その他カメラ
- ウェアラブルカメラ
- HDMIケーブル
- DVD・Blu-rayプレイヤー
- その他ゲーム機周辺機器
- その他Nintendo Switch
- Wii U周辺機器
- 無停電電源装置
- 冷却パッド
- マウスパッド
- ノートPC用バッテリー
- その他PCアクセサリー
- スクリーン保護フィルム
- ケーブル
- ウェブカメラ
- USBハブ
- PC用ヘッドセット
- PC用バッテリー
- PC用スピーカー
- OAクリーナー
- 語学
- 素材
- 教養
- 実用
- 会計
- ユーティリティ
- ホームページ作成
- プログラミング
- ネットワーク
- デザイン グラフィック
- その他PCソフト
- セキュリティ
- グラフィック
- OS
- Office
- メディアケース
- ブルーレイメディア
- カードリーダー
- USBメモリー
- SDメモリーカード
- DVD
- CD
- 無線LAN中継器
- 無線LANルーター
- 有線LAN中継器
- 有線LANルーター
- モデム
- その他ネットワーク用品
- スイッチングハブ
- 電源ユニット
- 外付けHDD
- 増設メモリー
- 内蔵型SSD
- 内蔵型HDD
- マザーボード
- その他PCパーツ
- グラフィックボード
- TVチューナー
- PCバッグ
- PCケース
- DVDドライブ
- CPUクーラー
- CPU
- 無線マウス
- 無線キーボード
- 有線マウス
- 有線キーボード
- マウスアクセサリー
- ペンタブレット
- テンキー
- ゲームマウス
- キーボードアクセサリー
- キーボード マウスセット
- ポータブルDVDドライブ
- ノートPC用メモリ
- 液晶モニター
- プロジェクタースクリーン
- プロジェクター
- PCアクセサリー
- 中古ノートPC
- ノートPC
- Mac ノート
- 詰め替えインク
- 純正インク
- 互換インク
- リサイクル
- トナー
- PCその他
- コピー用紙
- タブレット用タッチペン
- タブレット用スタンド
- タブレット保護フィルム
- タブレットケース
- その他タブレットアクセサリー
- iPad保護フィルム
- iPad ケース
- 複合機
- 写真用紙
- レーザープリンタ
- パソコンその他
- スキャナー
- シュレッダー
- インクジェットプリンタ
- 3Dプリンター
- Digitalその他
- Windowsタブレット
- iPad
- Androidタブレット
- 中古PC
- デスクトップPC
- デジタルその他
- スティックPC
-
スマートフォン
- その他スマホ・タブレット・モバイル通信
- 作業服
- 携帯電話ケース
- 車載アクセサリー
- 変換アダプター
- タブレットPC用カバー・ケース
- タッチペン・スタイラス(スマホ・タブレット用)
- その他スマホアクセサリー
- セルカ棒
- スマホスタンド
- スマホケース
- スマホ・タブレット用ケーブル
- カメラレンズ
- アームバンド・ホルスター
- 海外用Wi-Fiレンタル
- 国内用Wi-Fiレンタル
- Wi-Fi関連機器
- SIMカード
- スマホ用USBメモリー
- microSDカード
- 自撮り棒
- ホールドリング
- タッチペン
- その他スマホアクセサリー
- スマホ用修理パーツ
- スマホ用三脚
- スマホ用カメラレンズ
- スマートフォンストラップ
- スタンド
- VRゴーグル
- ヘッドホン
- その他スマホ周辺機器
- スピーカー
- イヤホンジャック
- イヤホン
- FMトランスミッター
- モバイルバッテリー
- 車載用充電器
- Type-C
- micro USBケーブル
- iPhone Lightning ケーブル
- AC/コンセント充電器
- スマートウォッチアクセサリ
- スマートウォッチ
- Apple Watch
- 中古スマホ本体
- その他SIMフリー本体
- スマートフォンXperia
- スマートフォンiPhone
- スマートフォンHuawei
- スマートフォンGalaxy
- Fujitsu
- ASUS
-
スマホケース
- その他Android保護フィルム
- ZenFone
- Xperia
- iPhone
- Huawei
- Galaxy Tab & NOTE保護フィルム
- GALAXY
- ARROWS
- AQUOS PHONE
- その他スマホケース
- ZenFone スマホケース
- REGZA PHONEケース
- Nexusケース
- MEDIASケース
- Huawei スマホケース
- HTCケース
- ポーチ マルチ対応ケース
- AQUOS
- ARROWS NX
- ARROWS Fit
- Galaxy S9+
- Galaxy S9
- GALAXY S8+
- GALAXY S8
- GALAXY S7
- Galaxy S6
- GALAXY Note edge
- Xperia Z
- Xperia XZ
- Xperia X
- iPhoneX
- iPhoneSE
- iPhone7 8 Plus
- iPhone7 8
- iPhone6 6s Plus
- iPhone6 6s
- iPhone4 5
- iPhone Xs Max
- iPhone Xs
- iPhone XR
- iPhone 11 Pro Max
- iPhone 11 Pro
- iPhone 11
-
Outdoor
-
アウトドア、釣り、旅行用品
- 塗料 接着剤
- 餌(冷凍)
- その他ルアー フライ
- アウトドア、旅行携行食品
- カジュアルスーツケース
- スーツケースカバー
- スーツケースベルト
- ソフトタイプスーツケース
- トランクタイプスーツケース
- ハードタイプスーツケース
- 機内持込み(ソフトタイプ)
- 機内持込み(トランクタイプ)
- 機内持込み(ハードタイプ)
- TSAロック
- スキミング防止グッズ
- セキュリティケース
- その他
- バックパックカバー
- ワイヤー、ケーブルロック
- 防犯ブザー
- 貴重品入れ
- 南京錠
- アイマスク
- グルーミング、爪切りセット
- トラベルクロック
- フットレスト
- 安眠グッズ
- 耳栓
- 旅行用シャンプーセット
- 旅行用歯みがきセット
- 旅行用化粧品セット
- 使い捨て下着
- 首枕、ネックピロー
- 洗濯セット
- 携帯用スリッパ
- 携帯用ソーイングセット
- 衣類圧縮袋
- 酔い止めバンド
- ガーメントバッグ
- キャリーカート
- トラベルポーチ
- ネームタグ
- ネクタイケース
- パスポートケース、カバー
- ボストンバッグ
- ラゲッジチェッカー
- 巾着袋
- 旅行かばん備品、小物
- 折りたたみバッグ
- その他
- 変換プラグ
- 変圧器、アダプター
- 翻訳機
- 海外用ドライヤー
- 湯沸かし器、トラベルケトル
- インド
- インドネシア
- カンボジア
- シンガポール
- スリランカ
- ソウル
- その他
- タイ
- バリ島
- フィリピン
- プーケット
- ベトナム
- マカオ
- マレーシア
- ミャンマー
- モンゴル
- 韓国
- 上海
- 台湾
- 香港
- 中国
- アラスカ
- カナダ
- サンフランシスコ
- シアトル
- その他
- ニューヨーク
- ボストン
- ラスベガス
- ロサンゼルス
- オーストラリア
- その他
- ニュージーランド
- その他
- グアム
- サイパン
- その他
- タヒチ
- ニューカレドニア
- パラオ
- ハワイ、ワイキキ
- モルディブ
- イギリス
- イタリア
- オーストリア
- オランダ
- クロアチア
- スイス
- スウェーデン
- スペイン
- その他
- チェコ
- デンマーク
- ドイツ
- パリ
- ハンガリー
- フィンランド
- フランス
- ベルギー
- ロシア
- ロンドン
- その他
- ドバイ
- トルコ
- ブラジル
- ペルー
- メキシコ
- ヒップウェーダー
- その他釣り具
- Tシャツ
- インナーウエア
- グローブ
- その他フィッシングウェア
- パーカー
- ヒップガード
- フィッシングジャケット
- フィッシングスーツ(上下セット)
- フィッシングパンツ
- フィッシングベスト
- フィッシングベルト
- ライフジャケット
- レインウエア
- 帽子
- 鮎タイツ
- ウェーディングシューズ
- スパイクシューズ
- フィッシングシューズ
- フィッシングブーツ
- 鮎タビ
- 替え底
- エアーポンプ
- ギャフ
- コマセミキサー
- スカリ、ビク
- その他フィッシングツール
- タモ網、ランディングネット
- はさみ、ラインカッター
- バッカン、バケツ
- ピトン
- フィッシュグリップ
- フィッシングナイフ
- フィッシングプライヤー
- フィッシングメジャー、はかり
- ヘッドライト、ヘッドランプ
- ヘラテント、パラソル
- やすり、フックシャープナー
- ロッドスタンド
- ロッドホルダー
- ワカサギテント
- 補修工作用品
- 釣り台
- 鮎引舟、オトリ缶
- 撒き餌杓
- 水中集魚灯
- 魚群探知機
- 針結び器
- 針外し
- タックルボックス
- フィッシングバッグ
- リールケース
- ルアー、フライケース
- ロッドケース
- ロッドベルト
- 餌箱
- 浮きケース
- フローター備品、アクセサリー
- フローター本体
- スピニングリール
- スピンキャストリール
- チヌ、石鯛リール
- フライリール
- ベイトリール(ルアー用)
- リールパーツ
- スピニングリールパーツ
- その他リールパーツ
- チヌ、石鯛リールパーツ
- フライリールパーツ
- ベイトリールパーツ
- リールスタンド
- リール用オイル、グリス
- 両軸、電動リールパーツ
- ワカサギリール
- 電動リール
- 両軸リール
- ジグヘッド
- スイムベイト
- その他ソフトルアー
- ソフトルアーアクセサリー
- フロッグ
- ラバージグ
- ワーム
- エギ、餌木
- クランクベイト
- ジグスピナー
- ジグミノー
- シャッド
- スピナー
- スピナーベイト
- スピンテールジグ
- スプーン
- その他ハードルアー
- トップウォーター
- ハードルアーアクセサリー
- バイブレーションルアー
- ビッグベイト
- ミノー、プラグ
- メタルジグ
- タイイングツール
- フライマテリアル
- 完成品フライ
- アジングロッド
- エギングロッド
- オフショアロッド
- シーバスロッド
- ジギングロッド
- ショアジギングロッド
- その他ロッド、釣り竿
- その他淡水ロッド
- タイラバロッド
- チニングロッド
- チヌ竿
- トラウトロッド
- バスロッド
- フライロッド
- フラットフィッシュロッド
- ヘラブナ竿
- ライギョ、ナマズロッド
- ライトジギングロッド
- ルアーロッド
- ロックフィッシュロッド
- ガイド
- グリップ
- その他ロッドパーツ
- ブランク
- 穂先糸
- 握り糸
- ワカサギ竿
- 船竿
- 磯竿
- 鯉竿
- 鮎竿
- 投げ竿
- 渓流竿
- 加工エサ、練り餌
- 冷凍餌
- 生き餌
- 釣り竿セット
- ウキ
- オモリ
- ケミカルライト
- コマセカゴ
- サルカン、スイベル
- その他仕掛け用品
- テンヤ
- ヤエン
- ライン巻き器
- 釣り糸、ライン
- 釣り針
- 仕掛け
- 仕掛け巻
- 仕掛け用クッション
- 仕掛け用ビーズ
- 天秤
- 釣り用クーラーボックス
- 偏光グラス(釣り用)
- アンカーロープ、チェーン
- アンカー本体
- セーフティ、救命用具
- プレジャーボート、ヨット船体
- ボートトレーラー
- モーターボート機材、備品
- ヨット機材、備品
- 船外機、エンジン
- 航海計器
- 水上オートバイ機材、備品
- その他アウトドア用品
- カヌー、カヤック本体
- カヌー、ボート備品
- ゴムボート本体
- パドル、オール
- ライフジャケット
-
アウトドア、キャンプ、登山
- その他 ウィンタースポーツ
- ウィンタースポーツ レディースウェア
- コート
- ジャケット
- アームウォーマー
- ゲイター
- ネックウォーマー
- フェイスマスク、バラクラバ
- レッグウォーマー
- 帽子
- 手袋
- 靴下
- コンプレッションウェア(シャツ)
- コンプレッションウェア(タイツ)
- ショーツ
- スポーツブラ
- トップス
- トランクス、ブリーフ
- その他アウトドアウエア
- Tシャツ、アンダーシャツ
- シャツ、ポロシャツ
- その他トップス
- トレーナー
- パーカー
- フリース
- ベスト
- ショートパンツ
- スカート
- タイツ
- パンツ、ズボン
- ポンチョ
- レイングローブ
- レインコート
- レインジャケット
- レインスーツ(上下セット)
- レインハット
- レインパンツ
- 雨具小物
- アウトドアサンダル
- アプローチシューズ
- ウォーキングシューズ
- カジュアルシューズ
- クライミングシューズ
- スノーブーツ
- トレイルランニングシューズ
- マリン、ウォーターシューズ
- 登山靴、トレッキングシューズ
- 渓流靴
- アウトドアヒーター
- アウトドア時計
- アバランチビーコン
- コンパス(方位磁針)
- その他アウトドア精密機器
- ハンディGPS
- マップメジャー
- 気圧計、高度計
- 無線機
- インナーシーツ
- エアーベッド
- エアーベット用ポンプ
- クッション、エアークッション
- コット
- シュラフカバー
- スリーピングマット
- その他アウトドア寝具、備品
- 毛布、ブランケット
- マミー型寝袋
- 封筒型寝袋
- 人型寝袋
- 寝袋圧縮袋
- 枕、エアピロー
- アイゼン
- かんじき
- スノーシュー
- スノーショベル
- スノーソー
- ゾンデ棒
- ピッケル
- エマージェンシーシート
- ツェルト
- ポイズンリムーバー
- ホイッスル
- 酸素缶
- 携帯トイレ
- 携帯用浄水器
- 熊鈴
- クーラーバッグ、保冷バッグ
- クーラーボックス
- 保冷剤
- サンシェード
- パラソルスタンド、ベース
- ビーチパラソル
- ウィングタープ
- カーサイドタープ
- スクリーンタープ
- タープテント
- ヘキサタープ
- レクタタープ
- 大型シェルタータープ
- タープ部品、アクセサリー
- テント、タープ補修用品
- テントロープ
- ペグ
- ペグハンマー
- 撥水剤
- 自在金具
- アウトドアチェア
- アウトドアテーブル
- アウトドアベンチ
- テーブルチェアセット
- ハンモックアクセサリー
- ハンモックスタンド
- ハンモックチェア
- ハンモックテント
- 吊るしタイプ
- 自立式ハンモック
- イベント、避難用テント
- インナーシート、マット
- インナーテント
- 2ルームテント
- ドーム型テント
- ロッジテント
- ワンポールテント
- 着替え用テント
- グランドシート
- その他テント
- ツーリングテント
- テント部品、アクセサリー
- フライシート
- 山岳テント
- ナイフ、ツール
- アウトドアカセットコンロ
- クッカーセット
- ケトル
- コーヒードリッパー
- スキレット
- その他アウトドア調理器具
- ダッチオーブン
- パーコレーター
- フライパン
- ホットサンドクッカー
- ライスクッカー
- ロースター
- 飯盒、メスティン
- アルコールストーブ
- シングルバーナーコンロ
- その他燃焼器具
- ツーバーナーコンロ
- トーチバーナー
- ネイチャーストーブ
- ウインドスクリーン
- お玉
- キャンプグローブ
- ツールセット
- トライポッド
- トング、火ばさみ
- ブックマッチ
- フライ返し、ターナー
- まな板
- 火打石
- 火起こし器
- 火消し壺
- 焼き網
- 収納ケース
- 送風機
- 鉄板、グリル
- 網ブラシ
- 竹串、金串
- バーベキューコンロ
- 焚き火台
- 七輪
- カトラリー、箸
- シェラカップ
- ドライネット
- マグカップ、コップ
- 皿、ボウル
- 容器
- 食器セット
- 燻製器、スモーカー
- LEDランタン
- ガスランタン
- ガソリンランタン
- キャンドルランタン
- その他ライト、ランタン
- ヘッドライト、ヘッドランプ
- ランタンアクセサリー
- 灯油ランタン
- 懐中電灯、ハンディライト
- アウトドアポーチ
- ウエストバッグ
- ウォレット、財布
- キャリーバッグ
- キャリーワゴン
- ショルダーバッグ
- スタッフバッグ
- ダッフルバッグ
- ドライバッグ
- ナップザック
- バックパック、ザック
- ピクニックバスケット
- ベビーキャリア
- マップケース
- レインカバー、ザックカバー
- 背負子
- レジャーシート
- アウトドアストック
- アウトドアヘルメット
- アッセンダー
- カラビナ
- クイックドロー
- クライミングチョーク
- クライミングロープ
- クラッシュパッド
- スラックライン
- スリング
- その他クライミング用品
- チョークバッグ
- ディセンダー
- トレーニング用品
- ナッツ
- ハーケン
- ハーネス
- ハンマー
- ビレイデバイス
- プーリー
- ロープバッグ
- アルコール燃料
- アウトドア用ガス(OD缶)
- カセットガス(CB缶)
- スモークウッド
- スモークチップ
- その他アウトドア燃料
- ホワイトガソリン
- 固形燃料
- 燃料ボトル
- オガ炭
- 備長炭
- 練炭
- 木炭(一般)
- 薪
- 着火剤
- ウォータージャグ
- ウォータータンク
- スキットル
- ハイドレーション
- 水筒
-
アウトドア、釣り、旅行用品
-
Other
-
楽器、手芸、コレクション
- 業務、産業用
- 住宅設備
- ガラス工芸、ステンドグラス用品
- キャンドル作り用品
- シャドーボックス用品
- シルバークレイ道具、材料
- ステンシル用品
- その他手芸、ハンドクラフト用品
- ちりめん細工
- デコパージュ用品
- デコレーションパーツ
- ドールハウス
- トールペイント用品
- ぬいぐるみ材料
- ビーズ、アクセサリー道具、材料
- ペーパークラフト道具、材料
- ミシン
- レース編み道具、材料
- レザークラフト道具、材料
- 編み物道具、毛糸
- 裁縫道具
- 刺繍道具、材料
- 和洋裁材料
- 金属加工、彫金用具
- 木工道具、材料
- 人形作り
- 日本刺繍道具、材料
- 生地
- 陶芸道具、材料
- 押し花道具、材料
- 羊毛フェルト
- 粘土工芸道具、材料
- 実験、工作
- ガラス工芸
- その他美術、工芸品
- ポスター
- 彫刻
- 仏像
- 工芸品、民芸品
- 掛け軸
- 絵画
- 甲冑、模造刀
- 書道
- 陶芸
- 写真
- コミック画材
- その他画材、アート用品
- 版画用品
- 彫刻刀
- 額縁
- 画材用紙、工作紙
- 画用筆、鉛筆類
- 絵具、顔料
- 日本画用品
- 書道用具
- 水彩画用品
- 油絵用品
- 篆刻
- アートレプリカ
- アマチュア無線
- サバゲー、ミリタリー
- ステッカー
- その他コレクション、趣味
- タレントグッズ
- テレカ、プリペイドカード
- テレビ、アニメ、キャラクターグッズ
- ビンテージおもちゃ
- 貨幣、メダル、インゴット
- 切手、はがき
- 鉄道グッズ
- 映画グッズ
- 貯金箱
- キャラクター衣装
- ゴシック、ロリータ服
- サポート用品
- その他のコスプレ衣装
- バニーガール
- メイド服
- 小道具
- 衣装制作キット
- 制服
-
ゲーム、おもちゃ
- 大型遊具
- おもちゃ
- カードゲーム
- その他おもちゃ
- テレビゲーム
- トレーディングカード
- パーティグッズ
- パズル
- ビリヤード
- フィギュア
- ボードゲーム
- ミニカー
- ラジコン
- 乗用玩具
- 季節玩具
- 将棋
- 麻雀
- 模型、プラモデル
- 食玩、プライズ、カプセル
- 囲碁
- 碁盤
- 碁石
- 碁笥、碁笥箱、碁笥袋
- 囲碁セット
- 囲碁用品
- ゲームキャラクター
- コミック、アニメ
- その他食玩
- ヒーロー、特撮
- ミリタリー
- 乗り物
- 生き物
- オートバイ
- キャラクター
- その他模型
- ミニ四駆
- ミリタリー
- エアガン
- ミリタリー模型
- モデルガン
- ロボット
- 船、ボート
- 航空機
- 建物
- エナメル
- ラッカー
- 水性、アクリル
- スターターセット
- その他HOゲージ
- パワーパック
- レイアウト用品
- レール
- JR、国鉄車両
- アクセサリー、パーツ
- その他車両
- 貨物車
- 機関車
- 路面電車
- 私鉄、第3セクター車両
- 外国車両
- スターターセット
- その他Nゲージ
- パワーパック
- レイアウト用品
- レール
- JR、国鉄車両
- アクセサリー、パーツ
- その他車両
- 貨物車
- 機関車
- 路面電車
- 私鉄、第3セクター車両
- 外国車両
- Tゲージ
- Zゲージ
- その他鉄道模型
- 自動車
- 麻雀
- 将棋セット
- 将棋駒
- 将棋盤
- 将棋用品
- ケース飾り
- つるし飾り
- 雛人形小物
- 段飾り
- 平飾り
- 収納飾り
- その他花火
- 打ち上げ花火
- 花火セット
- 噴出し花火
- 手持ち花火
- ベランダ用
- 鯉のぼりグッズ
- 室内用
- 庭用
- その他水遊び玩具
- マット
- 浮き具
- 家庭用プール
- 水鉄砲
- 大将飾り、武者人形
- 兜飾り
- 鎧飾り
- 五月人形小物
- 車用ジュニアシート
- 乗用玩具一般
- 三輪車
- 一輪車
- 幼児用自転車
- 子ども用自転車
- オートバイ
- ドローン、ヘリ、航空機
- ミリタリー
- ラジコンパーツ、アクセサリー
- ロボット
- 船、ボート、潜水艦
- 自動車
- ミニカー
- ボードゲーム
- エイリアン
- グレムリン
- スターウォーズ
- スタートレック
- ソウ
- その他
- ターミネーター
- トイストーリー
- トランスフォーマー
- パイレーツオブカリビアン
- ハリーポッター
- プレデター
- ロボコップ
- X−メン
- アイアンマン
- アベンジャーズ
- スーパーマン
- スパイダーマン
- その他
- バットマン
- ハルク
- ToHeart2
- キングダムハーツ
- スーパーマリオ
- スーパーロボット大戦
- その他
- ドラゴンクエスト
- ファイナルファンタジー
- ペルソナ
- ポケモン
- モンスターハンター
- BLEACH
- ガンダム
- キン肉マン
- けいおん
- ゲッターロボ
- コードギアス
- ジョジョの奇妙な冒険
- セーラームーン
- その他
- となりのトトロ
- ドラゴンボール
- ナルト
- ハイキュー
- ベルセルク
- マジンガーZ
- ルパン三世
- ワンピース
- 北斗の拳
- 超時空要塞マクロス
- 初音ミク
- 攻殻機動隊
- 黒子のバスケ
- 艦隊これくしょん
- 進撃の巨人
- 涼宮ハルヒの憂鬱
- 弱虫ペダル
- 閃乱カグラ
- 聖闘士星矢
- 新世紀エヴァンゲリオン
- 銀魂
- 宇宙戦艦ヤマト
- 装甲騎兵ボトムズ
- サッカー
- その他
- プロレス、格闘技
- その他
- ウルトラマン
- ゴジラ
- その他
- 仮面ライダー
- フィギュアケース
- プライズ
- ミリタリー
- 創作、オリジナル
- 時代劇、仏像
- 芸能人、タレント
- ビリヤード
- キュー
- その他用具
- ビリヤードセット
- ビリヤード台
- ジグソーパズル
- パズルゲーム
- キャンドル
- クラッカー
- ジョークグッズ
- その他パーティーグッズ
- ビンゴ、くじ
- 室内装飾
- 手品
- トレーディングカード
- PSVita(ヴィータ)ソフト(コード販売)
- PSVita(ヴィータ)ソフト(パッケージ版)
- PSVita(ヴィータ)本体
- PSVita(ヴィータ)PSvitaTV
- PSVita(ヴィータ)アクセサリーセット
- PSVita(ヴィータ)イヤホン、スピーカー
- PSVita(ヴィータ)カードケース
- PSVita(ヴィータ)クレードル、グリップ
- PSVita(ヴィータ)ケーブル、アダプター
- PSVita(ヴィータ)スキンシール
- PSVita(ヴィータ)その他周辺機器
- PSVita(ヴィータ)ナスネ
- PSVita(ヴィータ)バッテリー、充電器
- PSVita(ヴィータ)プリペイドカード(カード販売)
- PSVita(ヴィータ)プリペイドカード(コード販売)
- PSVita(ヴィータ)ポーチ、ケース、カバー
- PSVita(ヴィータ)メモリーカード
- PSVita(ヴィータ)液晶保護フィルム
- Switchソフト(コード販売)
- Switchソフト(パッケージ版)
- Switch本体
- Switchカバー、ケース
- Switchケーブル、アダプター
- Switchコントローラー
- Switchその他周辺機器
- Switch充電器
- Wiiソフト(コード販売)
- Wiiソフト(パッケージ版)
- Wii本体
- Wii周辺機器
- WiiUソフト(コード販売)
- WiiUソフト(パッケージ版)
- WiiU本体
- カバー、ケース
- キーボード
- WiiUカバー、ケース
- WiiUキーボード
- WiiUケーブル、アダプター
- WiiUコントローラー
- WiiUスキンシール
- WiiUスタンド
- WiiUセンサーバー
- WiiUその他周辺機器
- WiiUプリペイドカード(カード販売)
- WiiUプリペイドカード(コード販売)
- WiiUヘッドセット
- WiiU充電ケーブル、スタンド
- XboxOneソフト(コード販売)
- XboxOneソフト(パッケージ版)
- XboxOne本体
- XboxOneカバー、ケース
- XboxOneキーボード
- XboxOneケーブル、アダプター
- XboxOneコントローラー
- XboxOneスキンシール
- XboxOneスタンド
- XboxOneその他周辺機器
- XboxOneプリペイドカード(カード販売)
- XboxOneプリペイドカード(コード販売)
- XboxOneヘッドセット
- ニンテンドー3DSソフト(コード販売)
- ニンテンドー3DSソフト(パッケージ版)
- ニンテンドー3DS本体
- ニンテンドー3DSアクセサリーセット
- ニンテンドー3DSイヤホン、スピーカー
- ニンテンドー3DSカードケース
- ニンテンドー3DSケーブル、アダプター
- ニンテンドー3DSスキンシール
- ニンテンドー3DSスライドパッド、グリップ
- ニンテンドー3DSその他周辺機器
- ニンテンドー3DSタッチペン
- ニンテンドー3DSバッテリー、充電器
- ニンテンドー3DSプリペイドカード(カード販売)
- ニンテンドー3DSプリペイドカード(コード販売)
- ポーチ、ケース、カバー
- 液晶保護フィルム
- ニンテンドーDS本体
- 周辺機器
- プリペイドカード(カード販売)
- プリペイドカード(コード販売)
- ソフト(コード販売)
- ソフト(パッケージ版)
- 本体
- カバー、ケース
- キーボード
- ケーブル、アダプター
- コントローラー
- スキンシール
- スタンド
- その他周辺機器
- ヘッドセット
- 充電ケーブル、スタンド
- プレイステーション4(PS4)ソフト(コード販売)
- プレイステーション4(PS4)ソフト(パッケージ版)
- プレイステーション4(PS4)本体
- カバー、ケース
- キーボード
- ケーブル、アダプター
- コントローラー
- スキンシール
- スタンド
- その他周辺機器
- ナスネ
- プリペイドカード(カード販売)
- プリペイドカード(コード販売)
- ヘッドセット
- 充電ケーブル、スタンド
- プレイステーションポータブル(PSP)ソフト(コード販売)
- プレイステーションポータブル(PSP)ソフト(パッケージ版)
- プレイステーションポータブル(PSP)本体
- アクセサリーセット
- イヤホン、スピーカー
- クレードル、グリップ
- ケーブル、アダプター
- スキンシール
- その他周辺機器
- ディスクケース
- バッテリー、充電器
- ポーチ、ケース、カバー
- メモリースティック
- 液晶保護フィルム
- NINTENDO64ソフト
- NINTENDO64本体
- NINTENDO64周辺機器
- PCFX
- PCFXソフト
- PCFX本体
- PCFX周辺機器
- PCエンジンソフト
- PCエンジン本体
- PCエンジン周辺機器
- Xboxソフト
- Xbox本体
- Xbox周辺機器
- Xbox360ソフト
- Xbox360本体
- カバー、ケース
- ケーブル、アダプター
- コントローラー
- センサーバー、キネクト
- その他周辺機器
- バッテリー、充電器
- ゲームキューブソフト
- ゲームキューブ本体
- ゲームキューブ周辺機器
- ゲームボーイソフトウェア
- ゲームボーイ本体
- ゲームボーイ周辺機器
- ゲームボーイアドバンスソフトウェア
- ゲームボーイアドバンス本体
- ゲームボーイアドバンス周辺機器
- スーパーファミコンソフト
- スーパーファミコン本体
- スーパーファミコン周辺機器
- セガサターン
- セガサターンソフト
- セガサターン本体
- セガサターン周辺機器
- その他テレビゲーム
- ドリームキャストソフト
- ドリームキャスト本体
- ドリームキャスト周辺機器
- ネオジオ
- ネオジオソフト
- ネオジオ本体
- ネオジオ周辺機器
- ファミコンソフト
- ファミコン本体
- ファミコン周辺機器
- プレイステーション(PS)ソフト
- プレイステーション(PS)本体
- プレイステーション(PS)周辺機器
- プレイステーション2(PS2)ソフト
- プレイステーション2(PS2)本体
- カバー、ケース
- キーボード
- ケーブル、アダプター
- コントローラー
- その他周辺機器
- メモリーカード
- メガドライブ
- メガドライブソフト
- メガドライブ本体
- メガドライブ周辺機器
- ワンダースワンソフト
- ワンダースワン本体
- ワンダースワン周辺機器
- その他おもちゃ
- かるた
- その他カードゲーム
- トランプ
- トレーディングカード
- 花札
- おしゃれ遊び
- おもちゃ箱
- おりがみ
- クレヨン
- スポーツ玩具
- その他おもちゃ
- ぬいぐるみ
- バーチャルペット
- ヒーロー遊び
- ヒロイン遊び
- ビンテージ、コレクション
- ブロック
- ままごと
- レールトイ
- 超合金、ロボット
- 乗り物、ミニチュア
- 電子玩具
- 積木
- その他人形
- ハウス、建物
- 抱き人形
- 服
- 人形、工芸品ケース
- 日本人形
- 着せかえ人形
- 遊具
- 楽器玩具
- 知育玩具
-
アダルト
- SM
- おもちゃ、道具
- コスチューム
- シチュエーション
- スカトロ
- その他プレイ
- フェチ
- プレイ
- 複数プレイ
- その他キャラクタータイプ
- 既婚、年上
- 職業
- その他
- その他外見、身体的特徴
- 処女
- 巨乳
- 貧乳、微乳
- グッズ
- ゲーム
- その他作品タイプ
- 同人誌
- AV女優
- スタイル
- タイプ
- 既婚
- アンリアル
- お色気職業
- コスチューム
- その他シチュエーション
- その他職業
- 病院
- 人気職業
- 聖職者
- 同性愛
- 未経験
- 学校
- その他
- おもちゃ、器具
- スカトロ
- その他プレイ
- ハードプレイ
- フェチ
- SM
- コスチューム
- シチュエーション
- その他プレイ
- ハード
- プレイ
- 複数プレイ
- お姫様、令嬢
- その他キャラクタータイプ
- 既婚、年上
- 職業
- その他
- その他外見、身体的特徴
- 処女
- 巨乳
- CD
- ゲーム
- その他ゲーム
- その他作品タイプ
- 調教用
- 拘束具
- 衣装
- エネマグラ
- シリコン
- その他
- ソフトビニール
- 電動(アナルグッズ)
- 拡張用
- OL
- アイドル
- シスター
- その他
- チアリーダー
- チャイナ
- バニーガール
- ボディコン
- ポリス
- メイド
- レースクィーン
- 和装
- 競泳、スクール水着
- 看護婦、ナース
- 体操着、ブルマ
- 学生服
- 制服
- 3箱パック
- ビッグサイズ
- 持続
- 極薄
- 無臭
- 香り付き
- ガーターベルト
- キャミソール
- ショーツ
- ストッキング
- セット(ブラジャー、ショーツ)
- ブラジャー
- ベビードール
- メンズショーツ
- 大きいサイズ(3L以上)
- その他
- ディルド
- ボディー、ピロー
- ラブドール
- IC制御
- クリバイブ
- シングルタイプ
- ハードタイプ
- パール
- 初心者向き
- 上級者向き
- 双頭タイプ
- 太め
- 無段階調整
- 細め
- Wホール
- アニメ系商品
- カップ
- その他
- 大型(オナホール)
- 電動
- 非貫通
- 貫通
- 簡易タイプ
- 女優系商品
- アナル専用
- スタンダードローション
- 温感、冷感タイプ
- 香り付き
- 業務用ローション(1リットル以上)
- エッグ
- 電マ
- 防水タイプ
- 静音仕様
- 抗菌仕様
- 携帯用
- アダルトゲーム
- アダルトブック
- アダルトグッズ
- アダルトアニメ
- アダルト雑誌
- アダルトDVD
-
カー用品・バイク用品
- バイク用カバー
- 電動ボードパーツ
- その他電動ボード
- 電動ボードアクセサリー
- バイク用レインウェア
- その他サイクルウェア その他ヘルメット
- バイク用グローブ
- ヘルメット用アクセサリー パーツ
- トラック用品
- 子供用 サイクルウェア ヘルメット
- ヘルメット
- レーシングスーツ
- つなぎ
- キャリア ラック
- エアバルブキャップ
- 洗車用品
- 内装
- 緊急・応急用品
- 芳香剤・消臭剤
- セキュリティ
- 盗難防止・セキュリティ
- ライト・ランプ
- メーター
- ヘッドライト・ウインカー・テールランプ
- ベスト
- バッテリー・メンテナンス用品
- ドライブレコーダー・セーフティ
- その他バイクパーツ
- その他タイヤ・ホイール
- その他カー用品
- カー用品グローブ
- カーナビ・カーオーディオ
- カーアクセサリー
-
ペット
- 保温 保冷用品
- その他
- キャットウェア アクセサリー
- エリザベスカラー
- ヘッドセット・イヤフォンマイク
- 食器・餌入れ・水入れ
- 浄水器・エアレーション用品
- 介護用マット・ベッド
- 給餌器
- ペット寝具・マット
- ペットケア
- はさみ・クリッパー・バリカン
- ドッグウェア・アクセサリー
- タライ・タブ・プール
- その他お手入れ・シャンプー・トリミング用品
- しつけ用品
- クレート・カート
- キャリー・クレート・カート
- お出かけ・お散歩用品
- おもちゃ
- 食器台 テーブル
- 食器
- 防虫 ノミ ダニ対策用品
- 衛生 掃除用品
- 肉球ケア用品
- 耳ケア用品
- 給水器 給餌器 フードディスペンサー
- 爪ケア用品
- 抜け毛取り
- 哺乳器
- ペット用仏具用品
- ブラッシングスプレー
- ブラシ
- フード計量器
- フードスプーン スコップ
- フードストッカー 容器
- フードクリップ フタ
- バリカン
- バス用品
- はさみ
- ドライヤー
- デンタルケア用品
- その他 ペット用品
- スキンケア用品
- シャンプー リンス
- 鳥用
- 魚用
- 猫用
- 犬用
- 爬虫類 両生類用
- 昆虫用
- 小動物用
- その他 小動物
- 餌やり、水やり用品
- 温室 ケース
- 底砂、底材
- ライト、照明器具
- フィルター、ろ材、ポンプ
- その他 爬虫類
- エサ
- 飼育セット
- 昆虫ケース
- 成虫用マット
- その他 昆虫
- エサ 昆虫
- 牧草
- ホイール
- ハンモック
- トイレタリー
- その他 ペット
- ケージ
- かじり木
- エサ ペット
- ウェア ペット
- 餌入れ
- 水浴び 砂浴び用品
- 止まり木
- その他 熱帯魚
- かご
- おもちゃ
- エサ 熱帯魚
- 貝 ヤドカリ
- 観賞魚
- 水槽 アクアリウム内装
- 水槽 アクアリウム
- 人工海水
- その他 Cat
- エビ ザリガニ
- エサ Cat
- 首輪 ハーネス
- 介護用品 Cat
- ベッド マット 寝具
- トイレ用品 Cat
- その他猫用品
- しつけ用品
- サプリメント
- ケージ ペット
- キャリーバッグ カート
- キャットフード
- キャットタワー
- キャットウェア
- お出かけ お散歩グッズ
- おもちゃ ペット
- オーナーズグッズ
- 犬首輪
- 犬小屋
- 犬ハーネス
- 介護用品 ペット
- リード
- ベッド マット 寝具 ペット
- ドライブ アウトドア
- ドッグフード
- ドッグウェア
- トイレ用品 ペット
- その他犬用品
- しつけ用品 ペット
- サプリメントSupplement
- ゲートGate
- ケージCage
- キャリーバッグ Carry Bag
- カート
- お出かけ お散歩グッズGoods
- おもちゃToy
- オーナーズグッズGoods
- インテリア 収納
- アジリティ 障害物競技
-
ホビー コスプレ
- その他 遊技機
- ビリヤード
- パチンコ
- パチスロ
- ダーツ
- ロープ
- リング
- ボール 手品
- ハンカチ 手品
- その他 手品
- コイン
- カード、トランプ
- 骨董品、アンティーク品
- 額縁
- 絵画
- 祭事
- 書
- 彫刻
- 工芸品、民芸品
- 化石
- 写真
- その他 アート
- ステンドグラス
- 電車
- 電気機関車
- 車両パーツ
- 貨物
- 蒸気機関車
- 線路
- 客車
- 制御機器、アクセサリー
- ディーゼル機関車
- ディーゼルカー
- その他 模型
- ストラクチャー、レイアウト
- 食玩、おまけ
- 雑誌
- 貨幣
- 切手
- ボトルキャップ
- フィギュア
- トレーディングカード、テレカ
- ソフビ人形
- その他コレクション
- その他
- キャラクタードール
- インゴット、金棒
- 装備、備品
- ライト
- モデルガン
- その他 ホビー
- スコープ
- エアガン
- BB弾
- 着ぐるみ
- 眼鏡 コスプレ
- 全身タイツ
- 仮面、マスク
- ワンピース コスプレ
- ブラウス
- ヒゲ
- パニエ、ドロワーズ
- ネクタイ コスプレ
- その他 コスプレ
- ソックス
- セパレート
- スカート コスプレ
- コスプレ用インナー
- コート、ジャケット
- キャップ、ヘッドアクセサリー
- かつら
- 雛祭り、こどもの日
- 販促品
- ハロウィン
- その他 Cos
- コスプレ 変装 仮装
- コスチューム一式
- クリスマス
- お祭り、縁日用品
- ウエディング
- イースター
-
楽器、手芸、コレクション

UV除菌ライト ミニサイズ UV除菌器 スマホ給電 紫外線除菌 除菌ライト UV-Cランプ iPhone Android対応
関連カテゴリ
- Fashion > Ladyレディース服 > その他スカート
販売価格:
¥0税込
波長:257nm
入力:3.3V-5V
輸出電圧:9.6V
紫外線出力:1W
重量:約15 g
サイズ:47*16*11mm
パッキングリスト:除菌ライト*1
生産国:中国
除菌の原理
紫外線(UV-C)の波長を利用して、細菌のDNA構造を破砕されます。短時間で細菌を効果的に除去できます。
日常の生活で簡単に除菌することができます。
体に無害で安心で使用できます。
スマホに給電式、使いやすい
スマホに接続するだけで使用できます。バッテリーや充電も必要ございません。
いつ手もどこでも簡単に使用できます。日々の生活により安全に!
2種類のソケット
iPhoneとandroid Micro USB両方に対応できます。スマホに合わせてご使用いただけます。
Micro USB Type-C変換アダプターも付きます。
様々な場所で大活躍!
化粧ブラシ、ドアハンドル、スマホ、 歯ブラシ、 お金、マスク、時計の除菌に適用します
いつでもどこでも身の回りの小物を除菌可能です。
コンパクトで携帯便利
超小型なミニサイズなので、携帯はとても便利です。
オフィス、家庭、出張、旅行など様々な場合でご使用できます。
※感染(侵入)を完全に防ぐものではありません。
※感染(侵入)を完全に防ぐものではありません。
入力:3.3V-5V
輸出電圧:9.6V
紫外線出力:1W
重量:約15 g
サイズ:47*16*11mm
パッキングリスト:除菌ライト*1
生産国:中国
除菌の原理
紫外線(UV-C)の波長を利用して、細菌のDNA構造を破砕されます。短時間で細菌を効果的に除去できます。
日常の生活で簡単に除菌することができます。
体に無害で安心で使用できます。
スマホに給電式、使いやすい
スマホに接続するだけで使用できます。バッテリーや充電も必要ございません。
いつ手もどこでも簡単に使用できます。日々の生活により安全に!
2種類のソケット
iPhoneとandroid Micro USB両方に対応できます。スマホに合わせてご使用いただけます。
Micro USB Type-C変換アダプターも付きます。
様々な場所で大活躍!
化粧ブラシ、ドアハンドル、スマホ、 歯ブラシ、 お金、マスク、時計の除菌に適用します
いつでもどこでも身の回りの小物を除菌可能です。
コンパクトで携帯便利
超小型なミニサイズなので、携帯はとても便利です。
オフィス、家庭、出張、旅行など様々な場合でご使用できます。
※感染(侵入)を完全に防ぐものではありません。
※感染(侵入)を完全に防ぐものではありません。










UV除菌ライト ミニサイズ UV除菌器



















